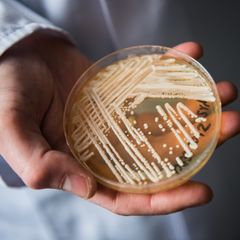

| |
Police News Review at 8 p.m. EST Daily
Current Police News: https://www.inoreader.com/stream/user/1006407045/tag/Police%20News%20Review/view/html?cs=m&sb=y
The News And Times - https://thenewsandtimes.blogspot.com/
Current Selected Articles: https://www.inoreader.com/stream/user/1006407045/tag/user-favorites/view/html
All Current Articles: https://www.inoreader.com/stream/user/1006407045/tag/all-articles/view/html |
|
|
|
| Man threatens police with knife in Des Moines - KCCI Des Moines |
| Man threatens police with knife in Des Moines KCCI Des Moines |
 "police" - Google News "police" - Google News | 23m | |
|
|
|
| Police presence reported in the San Jose area Tuesday - FirstCoastNews.com WTLV-WJXX |
| Police presence reported in the San Jose area Tuesday FirstCoastNews.com WTLV-WJXX |
 "police" - Google News "police" - Google News | 23m | |
|
|
|
| Lower Merion Township police: Armed suspect posed as solar worker during driveway... |
| Lower Merion Township police: Armed suspect posed as solar worker during driveway carjacking WPVI-TV |
 "police" - Google News "police" - Google News | 23m | |
|
|
|
| Inaugural COPA People's Academy looks to foster trust between community and police... |
| Inaugural COPA People's Academy looks to foster trust between community and police FOX 32 Chicago |
 "police" - Google News "police" - Google News | 23m | |
|
|
|
| Texas resident shoots, kills two intruders who broke into his apartment, police say... |
| Texas resident shoots, kills two intruders who broke into his apartment, police say Fox News |
 "police" - Google News "police" - Google News | 23m | |
|
|
|
| New member to Community Oversight Board brings student voice to ... - University... |
| New member to Community Oversight Board brings student voice to ... University of Colorado Boulder |
 "police" - Google News "police" - Google News | 23m | |
|
|
|
| Missing Woman Found Dead in Southeast DC: Police - NBC4 Washington |
| Missing Woman Found Dead in Southeast DC: Police NBC4 Washington |
 "police" - Google News "police" - Google News | 23m | |
|
|
|
| Police find drugs after man flees New Kensington traffic stop; felony ... - TribLIVE |
| Police find drugs after man flees New Kensington traffic stop; felony ... TribLIVE |
 "police" - Google News "police" - Google News | 23m | |
|
|
|
| Rapid police response prevents panic after Elder High School targeted by fake active... |
| Rapid police response prevents panic after Elder High School targeted by fake active shooter call WLWT... |
 "police" - Google News "police" - Google News | 23m | |
|
|
|
| Police, family continue to look for missing Mt. Penn woman - 69News WFMZ-TV |
| Police, family continue to look for missing Mt. Penn woman 69News WFMZ-TV |
 "police" - Google News "police" - Google News | 23m | |
|
|
|
| Police commissioner: Officers under scrutiny tried to save baby's life - Detroit... |
| Police commissioner: Officers under scrutiny tried to save baby's life Detroit Free Press |
 "police" - Google News "police" - Google News | 23m | |
|
|
|
| Missed training — including for use of force — led to 46 Mass. police suspensions... |
| Missed training — including for use of force — led to 46 Mass. police suspensions MassLive.com |
 "police" - Google News "police" - Google News | 23m | |
|
|
|
| Tampa police arrest armed man attempting entry at Mons Venus - Bay News 9 |
| Tampa police arrest armed man attempting entry at Mons Venus Bay News 9 |
 "police" - Google News "police" - Google News | 23m | |
|
|
|
| Toledo police searching for Wayne, Ohio teen last seen near Weiler Homes - WTOL |
| Toledo police searching for Wayne, Ohio teen last seen near Weiler Homes WTOL |
 "police" - Google News "police" - Google News | 23m | |
|
|
|
| Police ID victim hit by Amtrak Vermonter - WCAX |
| Police ID victim hit by Amtrak Vermonter WCAX |
 "police" - Google News "police" - Google News | 23m | |
|
|
|
| Alexandria's police department has diversity issues, some APD ... - ALXnow |
| Alexandria's police department has diversity issues, some APD ... ALXnow |
 "police" - Google News "police" - Google News | 23m | |
|
|
|
| Boone Police charge woman after she allegedly reported a false ... - Watauga Democrat |
| Boone Police charge woman after she allegedly reported a false ... Watauga Democrat |
 "police" - Google News "police" - Google News | 23m | |
|
|
|
| 2 adults, 1 child found dead at south Phoenix home - 12news.com KPNX |
| 2 adults, 1 child found dead at south Phoenix home 12news.com KPNX |
 "police" - Google News "police" - Google News | 23m | |
|
|
|
| Police investigating after three bodies found at home near 16th Street and Dobbins... |
| Police investigating after three bodies found at home near 16th Street and Dobbins Road ABC15 Arizona... |
 "police" - Google News "police" - Google News | 23m | |
|
|
|
| Daytona Beach police arrest driver, 23, accused of hitting toddler, fleeing scene... |
| Daytona Beach police arrest driver, 23, accused of hitting toddler, fleeing scene WFTV Orlando |
 "police" - Google News "police" - Google News | 23m | |
|
|
|
| San Jose police investigate family disturbance - KTVU FOX 2 San Francisco |
| San Jose police investigate family disturbance KTVU FOX 2 San Francisco |
 "police" - Google News "police" - Google News | 23m | |
|
|
|
| OKC police assisting US Marshals in search for escaped inmate - KOCO Oklahoma City |
| OKC police assisting US Marshals in search for escaped inmate KOCO Oklahoma City |
 "police" - Google News "police" - Google News | 23m | |
|
|
|
| Dallas police investigating after woman killed in suspected road rage shooting -... |
| Dallas police investigating after woman killed in suspected road rage shooting CBS News |
 "police" - Google News "police" - Google News | 23m | |
|
|
|
 | Lucy Liu took 'gorgeous' nude photos of Drew Barrymore on 'Charlie's Angels' set |
| The "Shazam! Fury of the Gods" actress admitted that she kept a series of risqué photos of Barrymore... |
 NY Post: NYPD Blotter NY Post: NYPD Blotter | 30m | |
|
|
|
 | Tobin Anderson has 'lofty' Iona goals after hard decision to leave Fairleigh Dickinson |
| Only 72 hours after Tobin Anderson led FDU over Purdue in only the second upset of a No. 1 seed by a... |
 NY Post: NYPD Blotter NY Post: NYPD Blotter | 30m | |
|
|
|
 | Lucy Liu reveals she took 'playful' naked photos of Drew Barrymore |
| "And you look gorgeous, as you still do," Liu told Barrymore on her talk show. |
 NY Post: NYPD Blotter NY Post: NYPD Blotter | 30m | |
|
|
|
 | Sofia Coppola's 'nepo baby' says she was grounded — for chartering helicopter |
| "They don't want me to be a nepotism kid, but TikTok is not gonna make me famous, so it doesn't really... |
 NY Post: NYPD Blotter NY Post: NYPD Blotter | 30m | |
|
|
|
 | I'll give women the chance to win my famous sperm: donor of 63 babies |
| Kyle Gordy, who has fathered 63 children across the globe, says he's open to starring in a reality TV... |
 NY Post: NYPD Blotter NY Post: NYPD Blotter | 30m | |
|
|
|
 | A very prompt and snappy day with NY Gov. Kathy Hochul |
| Cindy Adams discusses her day spent with New York Governor Kathy Hochul as they race around time. |
 NY Post: NYPD Blotter NY Post: NYPD Blotter | 30m | |
|
|
|
 | Inescapable 'forever chemicals' hurt pregnancy odds: 'Warning to women' |
| "What our study adds is that PFAS may also decrease fertility in women who are generally healthy and... |
 NY Post: NYPD Blotter NY Post: NYPD Blotter | 30m | |
|
|
|
 | Mets are limited in their Edwin Diaz relief options |
| Even if the Mets were open to a big move right now, it would not be easy to enact because no club wants... |
 NY Post: NYPD Blotter NY Post: NYPD Blotter | 30m | |
|
|
|
 | Eight dolphins die after becoming stranded on Jersey Shore beach |
| The bodies of the eight dolphins were transported to a lab for necropsies. |
 NY Post: NYPD Blotter NY Post: NYPD Blotter | 30m | |
|
|
|
 | Accused drug dealer charged with improperly disposing of Nathan Millard's body |
| Derrick Perkins, 45, was charged with improperly disposing of the body of Georgia father Nathan Millard,... |
 NY Post: NYPD Blotter NY Post: NYPD Blotter | 30m | |
|
|
|
 | 'Baywatch' babe Donna D'Errico jokes about launching bikini line 'for women over... |
| "Here's me modeling my new line of bathing suits for women over 50," the blond bombshell captioned a... |
 NY Post: NYPD Blotter NY Post: NYPD Blotter | 30m | |
|
|
|
 | NY hospital lobby effectively paid severance for Hochul campaign staffers with 'housekeeping'... |
| Good government groups are aghast that dozens of ex-staff for her campaign got paid by the state Democratic... |
 NY Post: NYPD Blotter NY Post: NYPD Blotter | 30m | |
|
|
|
 | NYC's illegal weed shops advertise city's open to criminals |
| Exotic Smoke Shop is one of 1,500 unlicensed, unregulated weed shops now crowding the five boroughs. |
 NY Post: NYPD Blotter NY Post: NYPD Blotter | 30m | |
|
|
|
 | One Vanderbilt workers panic after shaking felt in 93-story NYC skyscraper amid elevator... |
| One Vanderbilt, a 1,400-foot skyscraper next to Grand Central Terminal, "shook" after an elevator malfunctioned... |
 NY Post: NYPD Blotter NY Post: NYPD Blotter | 30m | |
|
|
|
 | Yankees' Josh Donaldson blasts two homers after tweaking stance |
| It was just one day, but after the last year, Josh Donaldson and the Yankees are encouraged by any positive... |
 NY Post: NYPD Blotter NY Post: NYPD Blotter | 30m | |
|
|
|
 | 'No talent at all': Biden tells Julia Louis-Dreyfus, Springsteen, Vera Wang he's... |
| "I'm going to talk with Julia about whether she like being VP or president better. I got to figure that... |
 NY Post: NYPD Blotter NY Post: NYPD Blotter | 30m | |
|
|
|
 | Union leaders enlist NY Democrats in key budget fights with Gov. Kathy Hochul |
| The governor is fighting unions aligned with Democratic lawmakers over top issues like healthcare funding,... |
 NY Post: NYPD Blotter NY Post: NYPD Blotter | 30m | |
|
|
|
 | Kelly Ripa: 'Insanely jealous' Mark Consuelos made marriage 'very hard' |
| Ripa — who married the actor in 1996 and shares three children with him — called his jealousy a "personality... |
 NY Post: NYPD Blotter NY Post: NYPD Blotter | 30m | |
|
|
|
 | Why Dolores Catania is 'afraid' to attend 'RHONJ' reunion |
| "On a good day, we have anxiety about the reunion," the reality TV star recently revealed. "Anxiety is... |
 NY Post: NYPD Blotter NY Post: NYPD Blotter | 30m | |
|
|
|
| NYPD: Bomb threats at 3 NYC locations found not credible - News 12 Brooklyn |
| NYPD: Bomb threats at 3 NYC locations found not credible News 12 Brooklyn |
 "NYPD" - Google News "NYPD" - Google News | 58m | |
|
|
|
| President Biden signs gun safety law: 'It's just common sense' - The Dialog |
| President Biden signs gun safety law: 'It's just common sense' The Dialog |
 "Robb Elementary Uvalde" - Google News "Robb Elementary Uvalde" - Google News | 1h | |
|
|
|
 | |
| Michael Novakhov retweeted: Interesting article by Twitter follower Sam... |
 Tweets by @mikenov Tweets by @mikenov | 1h | |
|
|
|
| |
| news.google.com/rss/articles/C… |
 Tweets by @mikenov Tweets by @mikenov | 1h | |
|
|
|
| NYPD searching for man who set 2 cruisers on fire in Flatiron District - CBS New... |
| NYPD searching for man who set 2 cruisers on fire in Flatiron District CBS New York |
 "NYPD" - Google News "NYPD" - Google News | 1h | |
|
|
|
| New information after 2 NYPD vehicles damaged in fire - CBS New York |
| New information after 2 NYPD vehicles damaged in fire CBS New York |
 "NYPD" - Google News "NYPD" - Google News | 1h | |
|
|
|
| New information after 2 NYPD vehicles damaged in fire - Yahoo News |
| New information after 2 NYPD vehicles damaged in fire Yahoo News |
 "NYPD" - Google News "NYPD" - Google News | 1h | |
|
|
|
| Man critically shot in DeKalb County neighborhood, police say - WSB Atlanta |
| Man critically shot in DeKalb County neighborhood, police say WSB Atlanta |
 "police" - Google News "police" - Google News | 1h | |
|
|
|
| Police searching for carjacking suspect who posed as a solar power ... - FOX 29 Philadelphia |
| Police searching for carjacking suspect who posed as a solar power ... FOX 29 Philadelphia |
 "police" - Google News "police" - Google News | 1h | |
|
|
|
| 3 bodies found at Arizona home; police investigating as triple homicide - Fox News |
| 3 bodies found at Arizona home; police investigating as triple homicide Fox News |
 "police" - Google News "police" - Google News | 1h | |
|
|
|
| California bill would ban police dogs from arrests and crowd control, citing racial... |
| California bill would ban police dogs from arrests and crowd control, citing racial bias, trauma Fox... |
 "police" - Google News "police" - Google News | 1h | |
|
|
|
| Fight led to Northwest Roanoke shooting, police say - WSLS 10 |
| Fight led to Northwest Roanoke shooting, police say WSLS 10 |
 "police" - Google News "police" - Google News | 1h | |
|
|
|
| 3 bodies found at south Phoenix home; homicide investigation underway - Arizona's... |
| 3 bodies found at south Phoenix home; homicide investigation underway Arizona's Family |
 "police" - Google News "police" - Google News | 1h | |
|
|
|
| Body found in Phoenix dumpster fire - 12news.com KPNX |
| Body found in Phoenix dumpster fire 12news.com KPNX |
 "police" - Google News "police" - Google News | 1h | |
|
|
|
| Woman leads police on chase in Norfolk after hitting officer in parking lot - 13newsnow.com... |
| Woman leads police on chase in Norfolk after hitting officer in parking lot 13newsnow.com WVEC |
 "police" - Google News "police" - Google News | 1h | |
|
|
|
| Tuesday Police Blotter - Samantha Laturno |
| Tuesday Police Blotter Samantha Laturno |
 "police" - Google News "police" - Google News | 1h | |
|
|
|
| Colorado dentist charged with murder in poisoning wife's protein shakes, police say... |
| Colorado dentist charged with murder in poisoning wife's protein shakes, police say cleveland.com |
 "police" - Google News "police" - Google News | 1h | |
|
|
|
| Violent youth fights at popular San Francisco mall prompt increased ... - The Santa... |
| Violent youth fights at popular San Francisco mall prompt increased ... The Santa Rosa Press Democrat |
 "police" - Google News "police" - Google News | 1h | |
|
|
|
| Euclid police: man uses stolen credit card for shopping spree - Cleveland 19 News |
| Euclid police: man uses stolen credit card for shopping spree Cleveland 19 News |
 "police" - Google News "police" - Google News | 1h | |
|
|
|
| Man charged with fleeing Casper police gets federal firearms charges - Oil City News |
| Man charged with fleeing Casper police gets federal firearms charges Oil City News |
 "police" - Google News "police" - Google News | 1h | |
|
|
|
| Jeffersonville police show bodycam footage of armed man shot by ... - WAVE 3 |
| Jeffersonville police show bodycam footage of armed man shot by ... WAVE 3 |
 "police" - Google News "police" - Google News | 1h | |
|
|
|
 | Putin-Xi summit should be a wakeup call on worldwide threats facing America |
| The only good news that might emerge from the meeting is that Westerners who didn't previously perceive... |
 NY Post: NYPD Blotter NY Post: NYPD Blotter | 2h | |
|
|
|
 | Meteorologist Alissa Carlson Schwartz reveals reason she collapsed in frightening... |
| "I do have a history of fainting. It's just when you're on a public platform, sometimes it happens and... |
 NY Post: NYPD Blotter NY Post: NYPD Blotter | 2h | |
|
|
|
 | Biden family paydays: Letters to the Editor — March 22, 2023 |
| The Issue: Reports that President Biden's daughter-in-law received $35,000 from a Chinese energy company.... |
 NY Post: NYPD Blotter NY Post: NYPD Blotter | 2h | |
|
|
|
 | Brooke Shields: I'm 'amazed I survived' being sexualized as a child |
| The actress, who notably played a child prostitute when she was just 11 years old on "Pretty Baby," also... |
 NY Post: NYPD Blotter NY Post: NYPD Blotter | 2h | |
|
|
|
 | British billionaire lists his 246-foot yacht for $150.66M |
| Hedge fund titan Michael Platt is looking to part ways with this glam Arrow vessel as his larger yacht,... |
 NY Post: NYPD Blotter NY Post: NYPD Blotter | 2h | |
|
|
|
 | Stew Leonard Jr. to open swimming school in memory of drowned son |
| Stew Leonard Jr. and his wife are set to open the Stewie the Duck Swim School, a 6,400-square foot aquatics... |
 NY Post: NYPD Blotter NY Post: NYPD Blotter | 2h | |
|
|
|
 | Stream It Or Skip It: 'Operation Fortune: Ruse de Guerre' on VOD, a Vanilla Guy Ritchie... |
| Ritchie and Jason Statham pair for the fourth time, and it's starting to feel like the fourth time. |
 NY Post: NYPD Blotter NY Post: NYPD Blotter | 2h | |
|
|
|
 | St. John's president's Rick Pitino bond a driving force in hire: 'Fire in the belly' |
| Two Sundays ago, Shanley and Pitino met for three hours, according to the president, and he came away... |
 NY Post: NYPD Blotter NY Post: NYPD Blotter | 2h | |
|
|
|
 | Devin McCourty: Mac Jones-Bailley Zappe debate split Patriots locker room |
| The Patriots offense was a catastrophe in 2022, both on the field and behind the scenes. |
 NY Post: NYPD Blotter NY Post: NYPD Blotter | 2h | |
|
|
|
 | Miami Beach not extending spring break curfew despite deadly shootings |
| Miami Beach Mayor Dan Gelber enacted a midnight curfew Sunday but clashed with commissioners Monday,... |
 NY Post: NYPD Blotter NY Post: NYPD Blotter | 2h | |
|
|
|
 | Check out this great deal we found on a 4-Pack of Apple AirTags |
| Great deal located. |
 NY Post: NYPD Blotter NY Post: NYPD Blotter | 2h | |
|
|
|
 | Amber alert issued after two US siblings, 9 and 16, go missing in Mexico |
| "Because of the circumstances of their disappearance, age and the time passed, the missing minors could... |
 NY Post: NYPD Blotter NY Post: NYPD Blotter | 2h | |
|
|
|
 | We found tickets for all SF Giants 2023 home games. Some are only $6. |
| Here's how to see the Giants for not so giant prices this season. |
 NY Post: NYPD Blotter NY Post: NYPD Blotter | 2h | |
|
|
|
 | Broadway shows are becoming embarrassingly cheap-looking |
| Welcome to Broadway! Please enjoy the bare minimum! |
 NY Post: NYPD Blotter NY Post: NYPD Blotter | 2h | |
|
|
|
 | Most Americans seek brands that share their environmental goals: poll |
| The survey also found that more people think large corporations have a greater responsibility to society... |
 NY Post: NYPD Blotter NY Post: NYPD Blotter | 2h | |
|
|
|
 | 'Love Is Blind' Host Nick Lachey Ordered To Complete Anger Management and Alcoholics... |
| The television host was charged with assault and battery. |
 NY Post: NYPD Blotter NY Post: NYPD Blotter | 2h | |
|
|
|
 | Council Speaker Adrienne Adams rips NYPD over budget-busting OT costs |
| Council Speaker Adrienne Adams ripped the police department's overtime costs as out of control and at... |
 NY Post: NYPD Blotter NY Post: NYPD Blotter | 2h | |
|
|
|
 | Almost half of cat and dog owners want tattoos of their pets: poll |
| Another 16% of those polled already have a pet-themed tattoo on their body. |
 NY Post: NYPD Blotter NY Post: NYPD Blotter | 2h | |
|
|
|
 | Luxury goods titan LVMH makes moves along NYC's Billionaires' Row |
| French conglomerate LVMH is relocating its US headquarters to 550 Madison Ave., as well as shuffling... |
 NY Post: NYPD Blotter NY Post: NYPD Blotter | 2h | |
|
|
|
| NYPD investigating two incidents of antisemitic vandalism in Rego ... - QNS |
| NYPD investigating two incidents of antisemitic vandalism in Rego ... QNS |
 "NYPD" - Google News "NYPD" - Google News | 2h | |
|
|
|
| Council Speaker Adrienne Adams rips NYPD over budget-busting OT costs - New York... |
| Council Speaker Adrienne Adams rips NYPD over budget-busting OT costs New York Post |
 "NYPD" - Google News "NYPD" - Google News | 2h | |
|
|
|
| NYPD: Bomb threats at 3 NYC locations found not credible - News 12 Bronx |
| NYPD: Bomb threats at 3 NYC locations found not credible News 12 Bronx |
 "NYPD" - Google News "NYPD" - Google News | 2h | |
|
|
|
| Warren police officials defend decision to transport 4-month-old baby in squad cruiser... |
| Warren police officials defend decision to transport 4-month-old baby in squad cruiser WDIV ClickOnDetroit |
 "police" - Google News "police" - Google News | 2h | |
|
|
|
| Carjackers stab Indiana rideshare driver, steal vehicle: police - WANE |
| Carjackers stab Indiana rideshare driver, steal vehicle: police WANE |
 "police" - Google News "police" - Google News | 2h | |
|
|
|
| Daytona Beach police arrest driver wanted in hit-and-run where toddler was hurt -... |
| Daytona Beach police arrest driver wanted in hit-and-run where toddler was hurt WESH 2 Orlando |
 "police" - Google News "police" - Google News | 2h | |
|
|
|
| Stamford Police Investigate Suspicious Death After Body Found in Park - NBC Connecticut |
| Stamford Police Investigate Suspicious Death After Body Found in Park NBC Connecticut |
 "police" - Google News "police" - Google News | 2h | |
|
|
|
| California bill would ban police dogs from arrests and crowd control, citing racial... |
| California bill would ban police dogs from arrests and crowd control, citing racial bias, trauma Fox... |
 "police" - Google News "police" - Google News | 2h | |
|
|
|
| Police: Youth shelter employee sexually assaults child, 2 others try ... - FOX 5... |
| Police: Youth shelter employee sexually assaults child, 2 others try ... FOX 5 Atlanta |
 "police" - Google News "police" - Google News | 2h | |
|
|
|
| Maryland man's death sparks investigation into West Virginia's state police - CBS... |
| Maryland man's death sparks investigation into West Virginia's state police CBS News |
 "police" - Google News "police" - Google News | 2h | |
|
|
|
| Hamden Police Arrest Driver Involved in Fatal June 2022 Motorcycle Crash - NBC Connecticut |
| Hamden Police Arrest Driver Involved in Fatal June 2022 Motorcycle Crash NBC Connecticut |
 "police" - Google News "police" - Google News | 2h | |
|
|
|
| UK police: Suspect arrested after man set alight near mosque - ABC News |
| UK police: Suspect arrested after man set alight near mosque ABC News |
 "police" - Google News "police" - Google News | 2h | |
|
|
|
| Students bravely stopped man from kidnapping their classmate: police - Insider |
| Students bravely stopped man from kidnapping their classmate: police Insider |
 "police" - Google News "police" - Google News | 2h | |
|
|
|
| Man arrested for trying to ram Riverside park rangers with car after ... - Los Angeles... |
| Man arrested for trying to ram Riverside park rangers with car after ... Los Angeles Times |
 "police" - Google News "police" - Google News | 2h | |
|
|
|
| Kenya police say 1 killed in opposition-led protests - The Associated Press |
| Kenya police say 1 killed in opposition-led protests The Associated Press |
 "police" - Google News "police" - Google News | 2h | |
|
|
|
| Amarillo Police: Armed man shot on Paramount Boulevard identified - KFDA |
| Amarillo Police: Armed man shot on Paramount Boulevard identified KFDA |
 "police" - Google News "police" - Google News | 2h | |
|
|
|
| Column: Local Latina police chief, Magda Fernandez, gets national ... - The San Diego... |
| Column: Local Latina police chief, Magda Fernandez, gets national ... The San Diego Union-Tribune |
 "police" - Google News "police" - Google News | 2h | |
|
|
|
| |
| Xi and Putin solidify their nations' 'strategic partnership and coordination' sc.mp/oc41?utm_sourc… via... |
 Tweets by @mikenov Tweets by @mikenov | 2h | |
|
|
|
| Inside NYPD's dismantling and takedown of 2 violent Queens gangs - FOX 5 New York |
| Inside NYPD's dismantling and takedown of 2 violent Queens gangs FOX 5 New York |
 "NYPD" - Google News "NYPD" - Google News | 2h | |
|
|
|
| Michigan House votes to end A-F school quality ranking system - Bridge Michigan |
| Michigan House votes to end A-F school quality ranking system Bridge Michigan |
 "Robb Elementary Uvalde" - Google News "Robb Elementary Uvalde" - Google News | 2h | |
|
|
|
| New Haven Police Chief Recommends Termination of 4 Officers After Man Was Left Paralyzed... |
| New Haven Police Chief Recommends Termination of 4 Officers After Man Was Left Paralyzed NBC Connecticut |
 "police" - Google News "police" - Google News | 2h | |
|
|
|
| Police: Youth shelter employee sexually assaults child, 2 others try to cover it... |
| Police: Youth shelter employee sexually assaults child, 2 others try to cover it up FOX 5 Atlanta |
 "police" - Google News "police" - Google News | 2h | |
|
|
|
| Virginia man gets 4 years for attacking police at Jan. 6 riot - NBC News |
| Virginia man gets 4 years for attacking police at Jan. 6 riot NBC News |
 "police" - Google News "police" - Google News | 2h | |
|
|
|
| Police investigate reports of shots fired in Glen Burnie - WBAL TV Baltimore |
| Police investigate reports of shots fired in Glen Burnie WBAL TV Baltimore |
 "police" - Google News "police" - Google News | 2h | |
|
|
|
| Man shot in the chest during daytime shooting in West Philadelphia, police say -... |
| Man shot in the chest during daytime shooting in West Philadelphia, police say FOX 29 Philadelphia |
 "police" - Google News "police" - Google News | 2h | |
|
|
|
| Police ID Man Shot and Killed in Waterbury Apartment Building - NBC Connecticut |
| Police ID Man Shot and Killed in Waterbury Apartment Building NBC Connecticut |
 "police" - Google News "police" - Google News | 2h | |
|
|
|
| Irvo Otieno's death is the latest example of how police are 'failing people' during... |
| Irvo Otieno's death is the latest example of how police are 'failing people' during mental health crises,... |
 "police" - Google News "police" - Google News | 2h | |
|
|
|
| Three Marco Island police officers suspended; mislead department - news.wgcu.org |
| Three Marco Island police officers suspended; mislead department news.wgcu.org |
 "police" - Google News "police" - Google News | 2h | |
|
|
|
| Sheriff accused of drunk driving was going 96 mph before crash, police report says... |
| Sheriff accused of drunk driving was going 96 mph before crash, police report says MLive.com |
 "police" - Google News "police" - Google News | 2h | |
|
|
|
| Michigan State Police searching for missing, endangered woman - WLNS |
| Michigan State Police searching for missing, endangered woman WLNS |
 "police" - Google News "police" - Google News | 2h | |
|
|
|
| Police in Ky. town investigating series of break-ins - WKYT |
| Police in Ky. town investigating series of break-ins WKYT |
 "police" - Google News "police" - Google News | 2h | |
|
|
|
| Appleton police search for fraud suspect accused of stealing $8,000 - WBAY |
| Appleton police search for fraud suspect accused of stealing $8,000 WBAY |
 "police" - Google News "police" - Google News | 2h | |
|
|
|
| Police searching for woman accused of abducting her child - Bangor Daily News |
| Police searching for woman accused of abducting her child Bangor Daily News |
 "police" - Google News "police" - Google News | 2h | |
|
|
|
| Baby pronounced dead after Warren police attempt to rush it to ... - WDIV ClickOnDetroit |
| Baby pronounced dead after Warren police attempt to rush it to ... WDIV ClickOnDetroit |
 "police" - Google News "police" - Google News | 2h | |
|
|
|
 | Tweets Review at 5 p.m. - Великобритания поставит Украине бронебойные... |
| ... |
 The News And Times The News And Times | 2h | |
|
|
|
| Family of teen killed by US Park Police demands accountability - WTOP |
| Family of teen killed by US Park Police demands accountability WTOP |
 "police" - Google News "police" - Google News | 3h | |
|
|
|
| House Democrats and the Biden administration prepare to revive 'defund the police'... |
| House Democrats and the Biden administration prepare to revive 'defund the police' Washington Examiner |
 "police" - Google News "police" - Google News | 3h | |
|
|
|
| Puzzling highway death part of West Virginia police probe - The Associated Press |
| Puzzling highway death part of West Virginia police probe The Associated Press |
 "police" - Google News "police" - Google News | 3h | |
|
|
|
| Pueblo Police announce 7 stolen vehicles recovered and 7 arrests - KKTV |
| Pueblo Police announce 7 stolen vehicles recovered and 7 arrests KKTV |
 "police" - Google News "police" - Google News | 3h | |
|
|
|
| Police: One dead after Saturday I-5 crash between Albany and ... - The Register-Guard |
| Police: One dead after Saturday I-5 crash between Albany and ... The Register-Guard |
 "police" - Google News "police" - Google News | 3h | |
|
|
|
| VIDEO: Warren Police rush to try to save 4-month-old, commissioner defends officers... |
| VIDEO: Warren Police rush to try to save 4-month-old, commissioner defends officers 'heroic' actions FOX... |
 "police" - Google News "police" - Google News | 3h | |
|
|
|
| Las Vegas police searching for burglary suspect in Summerlin area - Fox 5 Las Vegas |
| Las Vegas police searching for burglary suspect in Summerlin area Fox 5 Las Vegas |
 "police" - Google News "police" - Google News | 3h | |
|
|
|
| Selma Police Detective named Times-Journal First Responder of ... - Selma Times-Journal |
| Selma Police Detective named Times-Journal First Responder of ... Selma Times-Journal |
 "police" - Google News "police" - Google News | 3h | |
|
|
|
| Scottsville police arrest 1, find drugs and 'fraudulent' Social Security card during... |
| Scottsville police arrest 1, find drugs and 'fraudulent' Social Security card during search WBKO |
 "police" - Google News "police" - Google News | 3h | |
|
|
|
| Editorial: Louisville deserves a transparent, accountable police force - Courier... |
| Editorial: Louisville deserves a transparent, accountable police force Courier Journal |
 "police" - Google News "police" - Google News | 3h | |
|
|
|
| CCSD declines public records request after Durango police encounter - Fox 5 Las Vegas |
| CCSD declines public records request after Durango police encounter Fox 5 Las Vegas |
 "police" - Google News "police" - Google News | 3h | |
|
|
|
 | Not all kids are A+ students, Bragg vs. rule of law and other commentary |
| "Optimism bias" says "every student is capable of academic flourishing" and failure to flourish reveals... |
 NY Post: NYPD Blotter NY Post: NYPD Blotter | 3h | |
|
|
|
 | Gun-toting Florida dad rushes to daughter's apartment, turns tables on her abusive... |
| The father shot the suspect once in the chest with a handgun, according to police. |
 NY Post: NYPD Blotter NY Post: NYPD Blotter | 3h | |
|
|
|
 | TikTok is tracking data on dozens of state government websites: report |
| Cybersecurity company Feroot Security found at least 27 US state government websites have web-tracking... |
 NY Post: NYPD Blotter NY Post: NYPD Blotter | 3h | |
|
|
|
 | ESPN fires executive VP Rob King after alleged harassment |
| ESPN has fired executive vice president Rob King after he was accused of harassment, The Post has learned. |
 NY Post: NYPD Blotter NY Post: NYPD Blotter | 3h | |
|
|
|
 | Author Jodi Picoult reveals proper pronunciation of her name: 'Ummm' |
| "And that's why I always defaulted to the JP initials when I said it out loud," one fan admitted. "Because... |
 NY Post: NYPD Blotter NY Post: NYPD Blotter | 3h | |
|
|
|
 | 'Jeopardy!' contestant wins game with wrong answer: 'That guy got screwed' |
| Fans of "Jeopardy!" were in an uproar Monday night when a contestant was awarded $600 for a technically... |
 NY Post: NYPD Blotter NY Post: NYPD Blotter | 3h | |
|
|
|
 | STARZ 'Blindspotting' Season 2: Trailer, Release Date, What We Know |
| Blindspotting Season 2 is coming soon! |
 NY Post: NYPD Blotter NY Post: NYPD Blotter | 3h | |
|
|
|
 | 'Amateur hour': TV networks pass on Amy Robach and T.J. Holmes' 'desperate' return... |
| Major TV networks are steering clear of former "GMA3" co-hosts T.J. Holmes and Amy Robach as the disgraced... |
 NY Post: NYPD Blotter NY Post: NYPD Blotter | 3h | |
|
|
|
 | Bill Bradley mourns loss of Knicks legend Willis Reed: 'He was the captain' |
| Dollar Bill Bradley, like every Knicks fan, will never forget the sight of Captain Willis Reed limping... |
 NY Post: NYPD Blotter NY Post: NYPD Blotter | 3h | |
|
|
|
 | Lamar Jackson's Ravens future gets murkier: 'Ready to move on' |
| Lamar Jackson could be working the backchannels to try and maneuver his way out of Baltimore. |
 NY Post: NYPD Blotter NY Post: NYPD Blotter | 3h | |
|
|
|
 | Save $50 on the newest edition iPad on Amazon today |
| Apple deals for days. |
 NY Post: NYPD Blotter NY Post: NYPD Blotter | 3h | |
|
|
|
 | Save $70 on the Philips Sonicare ExpertClean Electric Toothbrush |
| Savings to make you smile. |
 NY Post: NYPD Blotter NY Post: NYPD Blotter | 3h | |
|
|
|
 | What Time Does 'The Mandalorian' Come On Disney+? 'Mandalorian' Season 3, Episode... |
| Bo-Katan Kryze takes the viral "keep your helmet on" challenge. |
 NY Post: NYPD Blotter NY Post: NYPD Blotter | 3h | |
|
|
|
 | DeAndre Hopkins trade rumors heat up after curious social media follows |
| As trade talks about DeAndre Hopkins are ramping up, the Cardinals receiver is raising eyebrows with... |
 NY Post: NYPD Blotter NY Post: NYPD Blotter | 3h | |
|
|
|
 | Home prices fall for first time in a decade after record-setting run |
| The decline in home prices ended a streak of 131 consecutive months of increase. |
 NY Post: NYPD Blotter NY Post: NYPD Blotter | 3h | |
|
|
|
 | Save 41% on this three pack of Native Deodorant today on Amazon |
| Amazon offers great deals on deodorant, naturally. |
 NY Post: NYPD Blotter NY Post: NYPD Blotter | 3h | |
|
|
|
 | 'Shazam 2' May Be Hitting Digital One Month After Opening in Theaters |
| After a lackluster box office performance, Shazam! Fury of the Gods might hit digital in April. |
 NY Post: NYPD Blotter NY Post: NYPD Blotter | 3h | |
|
|
|
 | MLB to stream all minor league games for free on Bally's casinos app |
| Major League Baseball owners have cut a deal with a casino giant to provide free broadcasts of all minor... |
 NY Post: NYPD Blotter NY Post: NYPD Blotter | 3h | |
|
|
|
 | Russian cruise missiles destroyed in Crimea blast, Ukraine says |
| Ukrainian authorities stopped short of taking responsibility for the attack but said the strike should... |
 NY Post: NYPD Blotter NY Post: NYPD Blotter | 3h | |
|
|
|
 | Chris 'Mad Dog' Russo signs new deal with ESPN |
| The Mad Dog's bark will continue to reach a mass TV audience. |
 NY Post: NYPD Blotter NY Post: NYPD Blotter | 3h | |
|
|
|
 | |
| Michael Novakhov retweeted: Великобритания поставит Украине бронебойные... |
 Tweets by @mikenov Tweets by @mikenov | 3h | |
|
|
|
| |
| Brett Stephens Describes Biden as Bismarck realcleardefense.com/articles/2023/… |
 Tweets by @mikenov Tweets by @mikenov | 3h | |
|
|
|
| |
| Selected Articles Review at 11 a.m. - Putin sticks to protocol during Chinese leader Xi's visit – The... |
 Tweets by @mikenov Tweets by @mikenov | 3h | |
|
|
|
| Puzzling highway death part of West Virginia police probe - The Washington Post |
| Puzzling highway death part of West Virginia police probe The Washington Post |
 "police" - Google News "police" - Google News | 3h | |
|
|
|
| Pueblo Police announce 7 stolen vehicles recovered 7 arrests - KKTV |
| Pueblo Police announce 7 stolen vehicles recovered 7 arrests KKTV |
 "police" - Google News "police" - Google News | 3h | |
|
|
|
| Police investigating two deadly shootings in Memphis - WREG NewsChannel 3 |
| Police investigating two deadly shootings in Memphis WREG NewsChannel 3 |
 "police" - Google News "police" - Google News | 3h | |
|
|
|
| Benton chief of police resigns, K9 retires - KSN-TV |
| Benton chief of police resigns, K9 retires KSN-TV |
 "police" - Google News "police" - Google News | 3h | |
|
|
|
| WHMI 93.5 Local News : Police Involved in High-Speed Chase in ... - WHMI |
| WHMI 93.5 Local News : Police Involved in High-Speed Chase in ... WHMI |
 "police" - Google News "police" - Google News | 3h | |
|
|
|
| Brendon Burns fatally shot by police in Rochester NY - Democrat & Chronicle |
| Brendon Burns fatally shot by police in Rochester NY Democrat & Chronicle |
 "police" - Google News "police" - Google News | 3h | |
|
|
|
| Police on scene of Birmingham's 4th killing in 36 hours - AL.com |
| Police on scene of Birmingham's 4th killing in 36 hours AL.com |
 "police" - Google News "police" - Google News | 3h | |
|
|
|
| Police: Northern NY man died of stab wounds, blunt force trauma - WCAX |
| Police: Northern NY man died of stab wounds, blunt force trauma WCAX |
 "police" - Google News "police" - Google News | 3h | |
|
|
|
| 18 arrested in St. Petersburg human trafficking sting: police - WFLA |
| 18 arrested in St. Petersburg human trafficking sting: police WFLA |
 "police" - Google News "police" - Google News | 3h | |
|
|
|
| Wichita police investigating early-morning drive-by shooting - KWCH |
| Wichita police investigating early-morning drive-by shooting KWCH |
 "police" - Google News "police" - Google News | 3h | |
|
|
|
| Police suspend search for missing teen Scottie Dean Morris - New York Post |
| Police suspend search for missing teen Scottie Dean Morris New York Post |
 "police" - Google News "police" - Google News | 3h | |
|
|
|
| Police investigating tire heist, vehicle theft and tip jar larceny in ... - ARLnow |
| Police investigating tire heist, vehicle theft and tip jar larceny in ... ARLnow |
 "police" - Google News "police" - Google News | 3h | |
|
|
|
| Lake City Police search for suspect accused using pitchfork to stab victim - WCJB |
| Lake City Police search for suspect accused using pitchfork to stab victim WCJB |
 "police" - Google News "police" - Google News | 3h | |
|
|
|
| Police: Arrest made in theft of funeral van containing body - WISN Milwaukee |
| Police: Arrest made in theft of funeral van containing body WISN Milwaukee |
 "police" - Google News "police" - Google News | 3h | |
|
|
|
| Charlottesville Police partnering with law enforcement organizations to tackle gun... |
| Charlottesville Police partnering with law enforcement organizations to tackle gun violence NBC 29 |
 "police" - Google News "police" - Google News | 3h | |
|
|
|
| NYPD: 1 dead, another injured in overnight shooting on White ... - News 12 Bronx |
| NYPD: 1 dead, another injured in overnight shooting on White ... News 12 Bronx |
 "NYPD" - Google News "NYPD" - Google News | 4h | |
|
|
|
| Civilian Complaint Review Board 'dumped' hundreds of cases on NYPD at last minute:... |
| Civilian Complaint Review Board 'dumped' hundreds of cases on NYPD at last minute: police sources New... |
 "NYPD" - Google News "NYPD" - Google News | 4h | |
|
|
|
| Kokomo police asking for help in locating missing woman - WISH TV Indianapolis, IN |
| Kokomo police asking for help in locating missing woman WISH TV Indianapolis, IN |
 "police" - Google News "police" - Google News | 4h | |
|
|
|
| Atlanta police release video related to shooting at gas station last week - FOX 5... |
| Atlanta police release video related to shooting at gas station last week FOX 5 Atlanta |
 "police" - Google News "police" - Google News | 4h | |
|
|
|
| Fayetteville police investigating Enoch Avenue homicide - The Fayetteville Observer |
| Fayetteville police investigating Enoch Avenue homicide The Fayetteville Observer |
 "police" - Google News "police" - Google News | 4h | |
|
|
|
| Group of students help save classmate from attempted kidnapping, police say - WBAL... |
| Group of students help save classmate from attempted kidnapping, police say WBAL TV Baltimore |
 "police" - Google News "police" - Google News | 4h | |
|
|
|
| Body at mall in Concord, large police investigation - KTVU FOX 2 San Francisco |
| Body at mall in Concord, large police investigation KTVU FOX 2 San Francisco |
 "police" - Google News "police" - Google News | 4h | |
|
|
|
| Nashville police officer mishandled case before woman was killed ... - Tennessean |
| Nashville police officer mishandled case before woman was killed ... Tennessean |
 "police" - Google News "police" - Google News | 4h | |
|
|
|
| Mental health crisis at Kirkwood park prompts police response - KTVI Fox 2 St. Louis |
| Mental health crisis at Kirkwood park prompts police response KTVI Fox 2 St. Louis |
 "police" - Google News "police" - Google News | 4h | |
|
|
|
| WATCH: Police arrest area assistant principal charged with engaging in prostitution... |
| WATCH: Police arrest area assistant principal charged with engaging in prostitution WHIO |
 "police" - Google News "police" - Google News | 4h | |
|
|
|
| Man fatally shot at South Dallas apartment, police say - The Dallas Morning News |
| Man fatally shot at South Dallas apartment, police say The Dallas Morning News |
 "police" - Google News "police" - Google News | 4h | |
|
|
|
| Police Officer ‘Conscious and Speaking' After Being Hit by Car in Western Mass.... |
| Police Officer 'Conscious and Speaking' After Being Hit by Car in Western Mass. NECN |
 "police" - Google News "police" - Google News | 4h | |
|
|
|
| Police identify burned body, man shot at Cary home - WRAL News |
| Police identify burned body, man shot at Cary home WRAL News |
 "police" - Google News "police" - Google News | 4h | |
|
|
|
| What Happened to Defunding the Seattle Police Department? - Seattle Met |
| What Happened to Defunding the Seattle Police Department? Seattle Met |
 "police" - Google News "police" - Google News | 4h | |
|
|
|
| Argument Over Cell Phone Results In Person's Arrest - And Other ... - The Chattanoogan |
| Argument Over Cell Phone Results In Person's Arrest - And Other ... The Chattanoogan |
 "police" - Google News "police" - Google News | 4h | |
|
|
|
| NYPD says it's 'ready' for protests if Trump is arrested - WZTV |
| NYPD says it's 'ready' for protests if Trump is arrested WZTV |
 "NYPD" - Google News "NYPD" - Google News | 4h | |
|
|
|
| Video shows 'Good Samaritan' helping NYPD take down armed suspect - Yahoo! Voices |
| Video shows 'Good Samaritan' helping NYPD take down armed suspect Yahoo! Voices |
 "NYPD" - Google News "NYPD" - Google News | 4h | |
|
|
|
| Uvalde police held off on confronting shooter because of the rifle he used: report... |
| Uvalde police held off on confronting shooter because of the rifle he used: report The Hill |
 "Robb Elementary Uvalde" - Google News "Robb Elementary Uvalde" - Google News | 4h | |
|
|
|
 | Hingham police warn of Snapchat nude photo scam targeting teens - CBS Boston |
| CBS Boston |
 "police" - Google News "police" - Google News | 4h | |
|
|
|
 | Avoid the Area: Collision closes SE California as police respond - WIBW |
| WIBW |
 "police" - Google News "police" - Google News | 4h | |
|
|
|
 | Fitchburg police investigating reports of shots fired | News | channel3000.com -... |
| Channel3000.com - WISC-TV3 |
 "police" - Google News "police" - Google News | 4h | |
|
|
|
 | New Haven police chief calls for officers in Randy Cox case to be fired - Connecticut... |
| Connecticut Public |
 "police" - Google News "police" - Google News | 4h | |
|
|
|
 | City Council to propose millions more for Memphis Police pay - WREG NewsChannel 3 |
| WREG NewsChannel 3 |
 "police" - Google News "police" - Google News | 4h | |
|
|
|
 | Iowa City police investigate reports of gunshots on Lakeside Drive - KCRG |
| KCRG |
 "police" - Google News "police" - Google News | 4h | |
|
|
|
 | Dothan man sets fire to home after argument: Police - WTVY |
| WTVY |
 "police" - Google News "police" - Google News | 4h | |
|
|
|
 | 2 Hawai'i police detectives involved in fatal shooting in Kona to ... - Big Island... |
| Big Island Now |
 "police" - Google News "police" - Google News | 4h | |
|
|
|
 | Little Rock police searching for missing 50 -year-old woman - KATV |
| KATV |
 "police" - Google News "police" - Google News | 4h | |
|
|
|
 | New surveillance video in case of Irvo Otieno, who died in police custody - CBS News |
| CBS News |
 "police" - Google News "police" - Google News | 4h | |
|
|
|
 | Sources: State Police blocks ex-leader's son from getting coveted ... - WBRZ |
| WBRZ |
 "police" - Google News "police" - Google News | 4h | |
|
|
|
 | Devils vs. Wild prediction: Grab this NHL pick on Tuesday, March 21 |
| The Minnesota Wild are up to their old tricks. |
 NY Post: NYPD Blotter NY Post: NYPD Blotter | 4h | |
|
|
|
 | Is 'Swarm' Based On A True Story? |
| Depends on how you define "true story." |
 NY Post: NYPD Blotter NY Post: NYPD Blotter | 4h | |
|
|
|
 | Court hearing in NY AG's fraud case against Trump delayed by bomb threat |
| A judge said that a fall trial date in the fraud suit against Donald Trump was "written in stone" — after... |
 NY Post: NYPD Blotter NY Post: NYPD Blotter | 4h | |
|
|
|
 | Stray Kids have just 6 U.S. concerts. How much are last-minute tickets? |
| Want a taste of the mala taste group live? Here's how to find them this spring. |
 NY Post: NYPD Blotter NY Post: NYPD Blotter | 4h | |
|
|
|
 | First Republic surges 50% after Janet Yellen pledges US banks support |
| San Francisco-based First Republic was up 51%, bouncing back after suffering a 90% drop this month --... |
 NY Post: NYPD Blotter NY Post: NYPD Blotter | 4h | |
|
|
|
 | Wendy Williams drinking alcohol again to 'celebrate' her 'new lease on life' |
| Eyewitnesses saw a "lonely" Williams drinking at Fresco by Scotto before she and a group made their way... |
 NY Post: NYPD Blotter NY Post: NYPD Blotter | 4h | |
|
|
|
 | Hyatt fortune heir buys LA's Garcia House for $12.5M |
| The John Lautner-designed gem -- known for its parabolic shape and chic time capsule aesthetic -- has... |
 NY Post: NYPD Blotter NY Post: NYPD Blotter | 4h | |
|
|
|
 | Devastating asteroid hitting the Earth more likely than previously thought: scientist |
| New research looked at previous sites and found that the impact may have been 10 times more destructive... |
 NY Post: NYPD Blotter NY Post: NYPD Blotter | 4h | |
|
|
|
 | Gaten Matarazzo Confesses His "Deep Fear" To Jimmy Fallon About Not Being Able To... |
| "Back to freelance," Matarazzo joked. |
 NY Post: NYPD Blotter NY Post: NYPD Blotter | 4h | |
|
|
|
 | Willis Reed, legendary Knicks Hall of Famer, dead at 80 |
| Willis Reed, the heart and soul of the Knicks' most recent NBA championship teams, and the man who gave... |
 NY Post: NYPD Blotter NY Post: NYPD Blotter | 4h | |
|
|
|
 | New York cars encased in ice after lake spray freezes vehicles to ground |
| A driver parked an SUV lakeside in Hamburg, New York, and came back to their car frozen from lake spray. |
 NY Post: NYPD Blotter NY Post: NYPD Blotter | 4h | |
|
|
|
 | US probes reports of steering glitch on newer Honda Civics |
| U.S. auto safety regulators are investigating complaints from Honda Civic drivers that their steering... |
 NY Post: NYPD Blotter NY Post: NYPD Blotter | 4h | |
|
|
|
 | 'Bikini cowgirl' Storm Hogan goes viral on TikTok |
| Storm Hogan rides, trains and exercises horses, and has her own business selling custom T-shirts. |
 NY Post: NYPD Blotter NY Post: NYPD Blotter | 4h | |
|
|
|
 | March Madness 2023 predictions: Long shot picks to make ahead of Sweet 16 |
| Do any of the long shots in the Sweet 16 actually have what it takes to win it all? |
 NY Post: NYPD Blotter NY Post: NYPD Blotter | 4h | |
|
|
|
 | Jamie Foxx Was Target of a $40,000 Scam on Set of New "Nightmare" Netflix Movie:... |
| Foxx allegedly called the cops on the employee, but the production's rumored troubles didn't end there. |
 NY Post: NYPD Blotter NY Post: NYPD Blotter | 4h | |
|
|
|
 | C.J. Gardner-Johnson shades Eagles after signing with Lions in NFL free agency |
| The newest member of the Lions believes Detroit's roster is a "little better" than his former team, the... |
 NY Post: NYPD Blotter NY Post: NYPD Blotter | 4h | |
|
|
|
 | Save big on celeb-loved labels during the Saks Friends & Family Sale |
| You don't have to be friends with a star to score savings on their favorites. Shop major markdowns on... |
 NY Post: NYPD Blotter NY Post: NYPD Blotter | 4h | |
|
|
|
 | Cameron Diaz comeback movie halted as co-star Jamie Foxx hit with $40K scam: reports |
| The chilly weather on the "Back in Action" set in London has also reportedly become a big issue, though... |
 NY Post: NYPD Blotter NY Post: NYPD Blotter | 4h | |
|
|
|
 | 46 best gifts and toys for 5-year-olds in 2023, according to experts |
| Shopping for a 5-year-old? Find the perfect gift here. |
 NY Post: NYPD Blotter NY Post: NYPD Blotter | 4h | |
|
|
|
 | My baby might be named after famous cartoon ghost — people are booing me |
| A mom thought she picked the perfect name for her baby — until people started booing her. |
 NY Post: NYPD Blotter NY Post: NYPD Blotter | 4h | |
|
|
|
| “There's Nowhere Else to Park,” Responds NYPD Chief Maddrey to Questioning... |
| "There's Nowhere Else to Park," Responds NYPD Chief Maddrey to Questioning About Illegal Police Parking... |
 "NYPD" - Google News "NYPD" - Google News | 5h | |
|
|
|
| NYPD says it's 'ready' for protests if Trump is arrested - WOAI |
| NYPD says it's 'ready' for protests if Trump is arrested WOAI |
 "NYPD" - Google News "NYPD" - Google News | 5h | |
|
|
|
| NYPD says it's 'ready' for protests if Trump is arrested - CNYcentral.com |
| NYPD says it's 'ready' for protests if Trump is arrested CNYcentral.com |
 "NYPD" - Google News "NYPD" - Google News | 5h | |
|
|
|
| NYPD's Hate Crime unit investigates threats against S.I. schools ... - SILive.com |
| NYPD's Hate Crime unit investigates threats against S.I. schools ... SILive.com |
 "NYPD" - Google News "NYPD" - Google News | 5h | |
|
|
|
| Joanna Schwartz's "Shielded: How the Police Became Untouchable" - Reason |
| Joanna Schwartz's "Shielded: How the Police Became Untouchable" Reason |
 "police" - Google News "police" - Google News | 5h | |
|
|
|
| West Mifflin police say woman and child reported missing have been found - WTAE Pittsburgh |
| West Mifflin police say woman and child reported missing have been found WTAE Pittsburgh |
 "police" - Google News "police" - Google News | 5h | |
|
|
|
| Five suspects in Bay County marijuana shop burglary, police chase charged with 27... |
| Five suspects in Bay County marijuana shop burglary, police chase charged with 27 counts MLive.com |
 "police" - Google News "police" - Google News | 5h | |
|
|
|
| Arkansas town has almost no police protection after tiff over chief's raise: 'Matter... |
| Arkansas town has almost no police protection after tiff over chief's raise: 'Matter of life or death' Fox... |
 "police" - Google News "police" - Google News | 5h | |
|
|
|
| Man shot and killed by police in Rochester's Park Avenue neighborhood identified... |
| Man shot and killed by police in Rochester's Park Avenue neighborhood identified 13WHAM-TV |
 "police" - Google News "police" - Google News | 5h | |
|
|
|
| St. Louis police investigating infant's death - KMOV4 |
| St. Louis police investigating infant's death KMOV4 |
 "police" - Google News "police" - Google News | 5h | |
|
|
|
| Law firm, some police lobbying hard against bill to rein in disability ... - Minnesota... |
| Law firm, some police lobbying hard against bill to rein in disability ... Minnesota Reformer |
 "police" - Google News "police" - Google News | 5h | |
|
|
|
| Man charged after leading police on chase, crashing near Highway 544, HCPD says -... |
| Man charged after leading police on chase, crashing near Highway 544, HCPD says WBTW |
 "police" - Google News "police" - Google News | 5h | |
|
|
|
| Little Rock police searching for missing woman - THV11.com KTHV |
| Little Rock police searching for missing woman THV11.com KTHV |
 "police" - Google News "police" - Google News | 5h | |
|
|
|
| Vancouver police searching for woman and her 8-year-old daughter, missing for more... |
| Vancouver police searching for woman and her 8-year-old daughter, missing for more than a week OregonLive |
 "police" - Google News "police" - Google News | 5h | |
|
|
|
| NYPD's Hate Crime unit investigates threats against Staten Island schools superintendent:... |
| NYPD's Hate Crime unit investigates threats against Staten Island schools superintendent: Report SILive.com |
 "NYPD" - Google News "NYPD" - Google News | 5h | |
|
|
|
| UK police: Suspect arrested after man set alight near mosque - The Hill |
| UK police: Suspect arrested after man set alight near mosque The Hill |
 "police" - Google News "police" - Google News | 5h | |
|
|
|
| Cincinnati Police Department faces 2029 cliff for staffing - The Cincinnati Enquirer |
| Cincinnati Police Department faces 2029 cliff for staffing The Cincinnati Enquirer |
 "police" - Google News "police" - Google News | 5h | |
|
|
|
| Wichita police help deliver Meals on Wheels - KSN-TV |
| Wichita police help deliver Meals on Wheels KSN-TV |
 "police" - Google News "police" - Google News | 5h | |
|
|
|
| Watch: Fleeing burglary suspect hits Sarasota police officer with car and takes off... |
| Watch: Fleeing burglary suspect hits Sarasota police officer with car and takes off FOX 13 Tampa |
 "police" - Google News "police" - Google News | 5h | |
|
|
|
| GRAPHIC: Sarasota police officer flipped by fleeing vehicle - WWSB |
| GRAPHIC: Sarasota police officer flipped by fleeing vehicle WWSB |
 "police" - Google News "police" - Google News | 5h | |
|
|
|
| NYPD all hands on deck, Capitol Police call in more manpower ahead of potential Trump... |
| NYPD all hands on deck, Capitol Police call in more manpower ahead of potential Trump arrest Fox News |
 "police" - Google News "police" - Google News | 5h | |
|
|
|
| Euclid police: man uses stolen credit card for shopping spree - Cleveland 19 News |
| Euclid police: man uses stolen credit card for shopping spree Cleveland 19 News |
 "police" - Google News "police" - Google News | 5h | |
|
|
|
| Police: Las Vegas man told cops he was high on mushrooms when he allegedly killed... |
| Police: Las Vegas man told cops he was high on mushrooms when he allegedly killed friend Fox 5 Las Vegas |
 "police" - Google News "police" - Google News | 5h | |
|
|
|
| Hundreds of cases of stolen beer recovered after pursuit, police say - WWNY |
| Hundreds of cases of stolen beer recovered after pursuit, police say WWNY |
 "police" - Google News "police" - Google News | 5h | |
|
|
|
| With approval of golf carts, police remind residents of required ... - Norfolk Daily... |
| With approval of golf carts, police remind residents of required ... Norfolk Daily News |
 "police" - Google News "police" - Google News | 5h | |
|
|
|
| New Haven police chief recommends terminating officers involved in Cox case - WTNH.com |
| New Haven police chief recommends terminating officers involved in Cox case WTNH.com |
 "police" - Google News "police" - Google News | 5h | |
|
|
|
| London police chief 'humbled' by withering report on force - The Associated Press |
| London police chief 'humbled' by withering report on force The Associated Press |
 "police" - Google News "police" - Google News | 5h | |
|
|
|
| Cincinnati police department looking to hire more recruits amid staffing issues -... |
| Cincinnati police department looking to hire more recruits amid staffing issues FOX19 |
 "police" - Google News "police" - Google News | 5h | |
|
|
|
| NYPD posts photo of brass knuckles, guns and other scary weapons allegedly seized... |
| NYPD posts photo of brass knuckles, guns and other scary weapons allegedly seized on Staten Island; man,... |
 "NYPD" - Google News "NYPD" - Google News | 6h | |
|
|
|
| NYPD prepares safety measures outside Trump Tower - News 12 Bronx |
| NYPD prepares safety measures outside Trump Tower News 12 Bronx |
 "NYPD" - Google News "NYPD" - Google News | 6h | |
|
|
|
| NYC Council Speaker Adams backs concept of reducing size and scope of NYPD, a key... |
| NYC Council Speaker Adams backs concept of reducing size and scope of NYPD, a key progressive pledge Yahoo... |
 "NYPD" - Google News "NYPD" - Google News | 6h | |
|
|
|
| Newborn boy abandoned outside home in Springfield, Massachusetts; police searching... |
| Newborn boy abandoned outside home in Springfield, Massachusetts; police searching for mother WCVB Boston |
 "police" - Google News "police" - Google News | 6h | |
|
|
|
| Chief: New Haven police officers in Randy Cox case should be fired - New Haven Register |
| Chief: New Haven police officers in Randy Cox case should be fired New Haven Register |
 "police" - Google News "police" - Google News | 6h | |
|
|
|
| Judge sentences former Nixa Police Dept. officer accused of sex crimes involving... |
| Judge sentences former Nixa Police Dept. officer accused of sex crimes involving a minor KY3 |
 "police" - Google News "police" - Google News | 6h | |
|
|
|
| Hundreds of cases of stolen beer recovered after pursuit, police say - WMTV – NBC15 |
| Hundreds of cases of stolen beer recovered after pursuit, police say WMTV – NBC15 |
 "police" - Google News "police" - Google News | 6h | |
|
|
|
| Police investigate how woman ends up dead in Fort Lauderdale - WPLG Local 10 |
| Police investigate how woman ends up dead in Fort Lauderdale WPLG Local 10 |
 "police" - Google News "police" - Google News | 6h | |
|
|
|
| New London Police searching for missing child, parent - WBAY |
| New London Police searching for missing child, parent WBAY |
 "police" - Google News "police" - Google News | 6h | |
|
|
|
| New London Police searching for missing child, parent - WMTV – NBC15 |
| New London Police searching for missing child, parent WMTV – NBC15 |
 "police" - Google News "police" - Google News | 6h | |
|
|
|
| 2 fighting dogs shot and killed by police after 3 adults hurt in Elizabeth, New Jersey... |
| 2 fighting dogs shot and killed by police after 3 adults hurt in Elizabeth, New Jersey WABC-TV |
 "police" - Google News "police" - Google News | 6h | |
|
|
|
| London's Metropolitan Police lets predators flourish, review concludes - CNN |
| London's Metropolitan Police lets predators flourish, review concludes CNN |
 "police" - Google News "police" - Google News | 6h | |
|
|
|
| Meriden Police Charge Person of Interest Amid Investigation Into Deadly Shooting... |
| Meriden Police Charge Person of Interest Amid Investigation Into Deadly Shooting NBC Connecticut |
 "police" - Google News "police" - Google News | 6h | |
|
|
|
| Police search for woman who triggered Amber Alert on Sunday night - Kennebec Journal... |
| Police search for woman who triggered Amber Alert on Sunday night Kennebec Journal and Morning Sentinel |
 "police" - Google News "police" - Google News | 6h | |
|
|
|
| Uvalde Cops Delayed School Shooting Response Over Fears Of AR-15: Report - Yahoo... |
| Uvalde Cops Delayed School Shooting Response Over Fears Of AR-15: Report Yahoo News |
 "Robb Elementary Uvalde" - Google News "Robb Elementary Uvalde" - Google News | 6h | |
|
|
|
 | When Does March Madness Return? March Madness 2023 Schedule |
| There's still time to fill out a Sweet 16 bracket. |
 NY Post: NYPD Blotter NY Post: NYPD Blotter | 6h | |
|
|
|
 | Colombia TV host faints during live show |
| Colombian TV presenter Elianis Garrido fainted and collapsed onto the studio floor during a live broadcast. |
 NY Post: NYPD Blotter NY Post: NYPD Blotter | 6h | |
|
|
|
 | Gwyneth Paltrow showed 'disregard for people' in ski accident: plaintiff |
| Gwyneth Paltrow appeared in court in Utah on Tuesday. |
 NY Post: NYPD Blotter NY Post: NYPD Blotter | 6h | |
|
|
|
 | Certified pre-owned: Biden speeds M1 Abrams tanks to Ukraine by using refurbs |
| The Pentagon is accelerating the delivery of Abrams tanks to Ukraine by sending refurbished older models,... |
 NY Post: NYPD Blotter NY Post: NYPD Blotter | 6h | |
|
|
|
 | Gwyneth Paltrow's kids: Meet the Goop founder's 2 children and 2 stepchildren |
| The Oscar winner welcomed daughter Apple and son Moses with Chris Martin before their divorce. She is... |
 NY Post: NYPD Blotter NY Post: NYPD Blotter | 6h | |
|
|
|
 | Adam Sandler Denies That Chris Rock Went Too Far With His Will Smith Jokes: "He Was... |
| The actor said Rock "was unbelievably relaxed, funny, thoughtful" in his special. |
 NY Post: NYPD Blotter NY Post: NYPD Blotter | 6h | |
|
|
|
 | Rick Pitino's plan for St. John's roster: Lots of new players, Joel Soriano named... |
| One standout player will stay at St. John's under Rick Pitino. Many others will be gone. |
 NY Post: NYPD Blotter NY Post: NYPD Blotter | 6h | |
|
|
|
 | Dodge unveils last super-fast gasoline muscle car, Challenger SRT Demon 170 |
| The car go from zero to 60 miles per hour in a scary 1.66 seconds, making it faster than even electric... |
 NY Post: NYPD Blotter NY Post: NYPD Blotter | 6h | |
|
|
|
 | Jennifer Lopez poses nude to show off new Revolve shoe collection |
| "Starting the week right," Lopez captioned the shots — and fans agreed, with one writing, "I think you've... |
 NY Post: NYPD Blotter NY Post: NYPD Blotter | 6h | |
|
|
|
 | Billy Porter Calls out Attacks on "People Who Are Othered" on 'The View': "We're... |
| The actor and activist got heated on today's episode as he decried anti-LGBTQ politics and America's... |
 NY Post: NYPD Blotter NY Post: NYPD Blotter | 6h | |
|
|
|
 | 'The View' Derailed By Fart Sound Coming From Sara Haines' Cup: "What Was That?" |
| "We get blamed for dropping gas when in fact it is a cup," Goldberg said. |
 NY Post: NYPD Blotter NY Post: NYPD Blotter | 6h | |
|
|
|
 | Pregnant Hilary Swank shows one of her twins 'flexing' in ultrasound photo |
| The "P.S. I Love You" actress, who is pregnant with twins with Philip Schneider, shared a new ultrasound... |
 NY Post: NYPD Blotter NY Post: NYPD Blotter | 6h | |
|
|
|
 | Adam Sandler defends friend Chris Rock's 'never' too far Will Smith jokes |
| Adam Sandler defended his friend Chris Rock Sunday, saying he "never" thought his fellow comedian went... |
 NY Post: NYPD Blotter NY Post: NYPD Blotter | 6h | |
|
|
|
 | Nick Lachey ordered to anger management, AA after accosting paparazzo |
| "I thought he was going to break his hand; that's how hard he was hitting the glass," photographer Jody... |
 NY Post: NYPD Blotter NY Post: NYPD Blotter | 6h | |
|
|
|
 | Adam Schefter explains his side of Aaron Rodgers 'lose my number' beef |
| Adam Schefter has expanded on his side of the story after Aaron Rodgers told him to "lose my number"... |
 NY Post: NYPD Blotter NY Post: NYPD Blotter | 6h | |
|
|
|
 | Lollapalooza announces star-studded 2023 lineup. Get tickets today |
| Who's headlining with Lana and Billie? You'll just have to click into the story to find out. |
 NY Post: NYPD Blotter NY Post: NYPD Blotter | 6h | |
|
|
|
 | I was mocked for calling a $60 purse 'luxury' — now I model for the brand |
| Her modeling career is in the bag. |
 NY Post: NYPD Blotter NY Post: NYPD Blotter | 6h | |
|
|
|
 | This Samsung StormWash dishwasher is over $350 off this week |
| Deals on dishwashers! |
 NY Post: NYPD Blotter NY Post: NYPD Blotter | 6h | |
|
|
|
 | 'Veep,' 'Office' stars, Springsteen flock to White House day after 'Ted Lasso' visit... |
| A Hollywood entourage was shouted down Monday at a press briefing. |
 NY Post: NYPD Blotter NY Post: NYPD Blotter | 6h | |
|
|
|
 | Russian musician famous for anti-war protest songs dies after falling through icy... |
| The founder of the Russian band Cream Soda, whose music was used during anti-war protests in Russia,... |
 NY Post: NYPD Blotter NY Post: NYPD Blotter | 6h | |
|
|
|
| Police arrest Santa Maria man for car vs. pedestrian hit-and-run ... - KEYT |
| Police arrest Santa Maria man for car vs. pedestrian hit-and-run ... KEYT |
 "police" - Google News "police" - Google News | 6h | |
|
|
|
| Report: Alabama's Tony Mitchell Drove 141 MPH Before Being Stopped by Police. - Sports... |
| Report: Alabama's Tony Mitchell Drove 141 MPH Before Being Stopped by Police. Sports Illustrated |
 "police" - Google News "police" - Google News | 6h | |
|
|
|
| Police kill two pit bulls after three people injured in Elizabeth - My Central Jersey |
| Police kill two pit bulls after three people injured in Elizabeth My Central Jersey |
 "police" - Google News "police" - Google News | 6h | |
|
|
|
| Man left brain dead by Montclair police after reportedly being beaten and shocked... |
| Man left brain dead by Montclair police after reportedly being beaten and shocked with a Taser has died,... |
 "police" - Google News "police" - Google News | 6h | |
|
|
|
| Appleton police search for fraud suspect accused of stealing $8,000 - WBAY |
| Appleton police search for fraud suspect accused of stealing $8,000 WBAY |
 "police" - Google News "police" - Google News | 6h | |
|
|
|
| Columbus police officer accused of OVI pleaded guilty to similar charge in 2019 -... |
| Columbus police officer accused of OVI pleaded guilty to similar charge in 2019 NBC4 WCMH-TV |
 "police" - Google News "police" - Google News | 6h | |
|
|
|
| Spokane Police activate Silver Alert for missing endangered man - KREM.com |
| Spokane Police activate Silver Alert for missing endangered man KREM.com |
 "police" - Google News "police" - Google News | 6h | |
|
|
|
| Tulsa police requesting public's assistance to identify person of ... - KTUL |
| Tulsa police requesting public's assistance to identify person of ... KTUL |
 "police" - Google News "police" - Google News | 6h | |
|
|
|
| Police return to Dauphin County property linked to 1989 cold case - PennLive |
| Police return to Dauphin County property linked to 1989 cold case PennLive |
 "police" - Google News "police" - Google News | 6h | |
|
|
|
| Duo Impersonates Cops In Botched Wash Heights Home Invasion: NYPD - Patch |
| Duo Impersonates Cops In Botched Wash Heights Home Invasion: NYPD Patch |
 "NYPD" - Google News "NYPD" - Google News | 6h | |
|
|
|
| NYC Council Speaker Adams backs concept of reducing size and ... - New York Daily... |
| NYC Council Speaker Adams backs concept of reducing size and ... New York Daily News |
 "NYPD" - Google News "NYPD" - Google News | 6h | |
|
|
|
| Manhattan arsonist sets fire to two NYPD cop cars - Yahoo News |
| Manhattan arsonist sets fire to two NYPD cop cars Yahoo News |
 "NYPD" - Google News "NYPD" - Google News | 6h | |
|
|
|
| Boardman police investigate theft of car found ditched in Youngstown - WKBN.com |
| Boardman police investigate theft of car found ditched in Youngstown WKBN.com |
 "police" - Google News "police" - Google News | 7h | |
|
|
|
| Indianapolis shooting: Police make arrest in hardware store shooting - IndyStar |
| Indianapolis shooting: Police make arrest in hardware store shooting IndyStar |
 "police" - Google News "police" - Google News | 7h | |
|
|
|
| Detroit eviction shooting leads police to guns, drugs, cash - FOX 2 Detroit |
| Detroit eviction shooting leads police to guns, drugs, cash FOX 2 Detroit |
 "police" - Google News "police" - Google News | 7h | |
|
|
|
| Austin police officer indicted, accused of excessive force - KXAN.com |
| Austin police officer indicted, accused of excessive force KXAN.com |
 "police" - Google News "police" - Google News | 7h | |
|
|
|
| Media Release 52- Homicide Investigation- 1st Avenue North ... - birminghamal.gov |
| Media Release 52- Homicide Investigation- 1st Avenue North ... birminghamal.gov |
 "police" - Google News "police" - Google News | 7h | |
|
|
|
| Dispatch: Police respond to Elder High School as precaution after false active shooter... |
| Dispatch: Police respond to Elder High School as precaution after false active shooter call made to 911 WCPO... |
 "police" - Google News "police" - Google News | 7h | |
|
|
|
| Police: Active shooter calls at Iowa schools are part of 'swatting' hoax - KCCI Des... |
| Police: Active shooter calls at Iowa schools are part of 'swatting' hoax KCCI Des Moines |
 "police" - Google News "police" - Google News | 7h | |
|
|
|
| Dallas police to release body camera video of officer shooting armed suspect - FOX... |
| Dallas police to release body camera video of officer shooting armed suspect FOX 4 News Dallas-Fort... |
 "police" - Google News "police" - Google News | 7h | |
|
|
|
| Amarillo Police: Armed man shot on Paramount Boulevard, threatened to harm innocent... |
| Amarillo Police: Armed man shot on Paramount Boulevard, threatened to harm innocent person KFDA |
 "police" - Google News "police" - Google News | 7h | |
|
|
|
| Middleton Police: Man dies following shooting outside of auto dealership - WKOW |
| Middleton Police: Man dies following shooting outside of auto dealership WKOW |
 "police" - Google News "police" - Google News | 7h | |
|
|
|
| Police to discuss next steps in search for missing Eaton teen - WISH TV Indianapolis,... |
| Police to discuss next steps in search for missing Eaton teen WISH TV Indianapolis, IN |
 "police" - Google News "police" - Google News | 7h | |
|
|
|
| One student killed, over 200 people arrested in Kenya protests -police - Reuters.com |
| One student killed, over 200 people arrested in Kenya protests -police Reuters.com |
 "police" - Google News "police" - Google News | 7h | |
|
|
|
| Heavily Decomposed Body Found In Hudson Valley, Police Need ... - Hudson Valley Post |
| Heavily Decomposed Body Found In Hudson Valley, Police Need ... Hudson Valley Post |
 "police" - Google News "police" - Google News | 7h | |
|
|
|
| Trump investigation: NYPD receives unfounded bomb threats as NYC gears up ahead of... |
| Trump investigation: NYPD receives unfounded bomb threats as NYC gears up ahead of possible indictment WABC-TV |
 "NYPD" - Google News "NYPD" - Google News | 7h | |
|
|
|
| Lake City police looking for man accused of stabbing someone with ... - WJXT News4JAX |
| Lake City police looking for man accused of stabbing someone with ... WJXT News4JAX |
 "police" - Google News "police" - Google News | 7h | |
|
|
|
| Police suspend search for teen who went missing in bizarre 'I hurt my brother' T-shirt... |
| Police suspend search for teen who went missing in bizarre 'I hurt my brother' T-shirt New York Post... |
 "police" - Google News "police" - Google News | 7h | |
|
|
|
| Miami woman accused of hitting her own belly while pregnant ... - WPLG Local 10 |
| Miami woman accused of hitting her own belly while pregnant ... WPLG Local 10 |
 "police" - Google News "police" - Google News | 7h | |
|
|
|
| Heavy police presence at New Haven hotel - WANE |
| Heavy police presence at New Haven hotel WANE |
 "police" - Google News "police" - Google News | 7h | |
|
|
|
| Albemarle police officer recovering following chase - The Stanly ... - Stanly News... |
| Albemarle police officer recovering following chase - The Stanly ... Stanly News & Press |
 "police" - Google News "police" - Google News | 7h | |
|
|
|
| California city pays $750K after police accused of painting swastika - Fox News |
| California city pays $750K after police accused of painting swastika Fox News |
 "police" - Google News "police" - Google News | 7h | |
|
|
|
| Akron Citizens' Police Review Board reopens applications - Cleveland 19 News |
| Akron Citizens' Police Review Board reopens applications Cleveland 19 News |
 "police" - Google News "police" - Google News | 7h | |
|
|
|
| Kenya Police Say 1 Killed in Opposition-Led Protests - U.S. News & World Report |
| Kenya Police Say 1 Killed in Opposition-Led Protests U.S. News & World Report |
 "police" - Google News "police" - Google News | 7h | |
|
|
|
| Woman loans car to unlicensed driver: Hinckley Township Police Blotter - cleveland.com |
| Woman loans car to unlicensed driver: Hinckley Township Police Blotter cleveland.com |
 "police" - Google News "police" - Google News | 7h | |
|
|
|
| Davenport woman ran over pedestrian, police allege - WHBF - OurQuadCities.com |
| Davenport woman ran over pedestrian, police allege WHBF - OurQuadCities.com |
 "police" - Google News "police" - Google News | 7h | |
|
|
|
| Former roommate steals game system: Brunswick Police Blotter - cleveland.com |
| Former roommate steals game system: Brunswick Police Blotter cleveland.com |
 "police" - Google News "police" - Google News | 7h | |
|
|
|
| Police Cars Set on Fire in New York as City Awaits Trump Indictment - Newsweek |
| Police Cars Set on Fire in New York as City Awaits Trump Indictment Newsweek |
 "police" - Google News "police" - Google News | 7h | |
|
|
|
| Two men sought in pair of robberies on board F train in Queens ... - QNS |
| Two men sought in pair of robberies on board F train in Queens ... QNS |
 "NYPD" - Google News "NYPD" - Google News | 7h | |
|
|
|
| Woman Shot In Broad Daylight On Oakland Gardens Street: NYPD - Patch |
| Woman Shot In Broad Daylight On Oakland Gardens Street: NYPD Patch |
 "NYPD" - Google News "NYPD" - Google News | 7h | |
|
|
|
| 'Morning Joe' Tells Trump Rioters to Get Ready for Arrest - TheWrap |
| 'Morning Joe' Tells Trump Rioters to Get Ready for Arrest TheWrap |
 "NYPD" - Google News "NYPD" - Google News | 7h | |
|
|
|
| Unfounded bomb threats called in against Manhattan DA, courts, NYPD HQ, as potential... |
| Unfounded bomb threats called in against Manhattan DA, courts, NYPD HQ, as potential Trump indictment... |
 "NYPD" - Google News "NYPD" - Google News | 7h | |
|
|
|
 | Tobin Anderson lands Iona job after FDU's miracle March Madness run |
| Tobin Anderson will be the next coach of Iona after he led Fairleigh Dickinson to a stunning 63-58 upset... |
 NY Post: NYPD Blotter NY Post: NYPD Blotter | 7h | |
|
|
|
 | Stranger shoves man into moving NYC train |
| The 36-year-old victim was standing on the platform at 59th Street in Sunset Park just after 6 p.m. Sunday... |
 NY Post: NYPD Blotter NY Post: NYPD Blotter | 7h | |
|
|
|
 | Marvel reeling after exec Victoria Alonso surprisingly ditches role |
| Marvel Studios is reeling from the exit of major executive Victoria Alonso. |
 NY Post: NYPD Blotter NY Post: NYPD Blotter | 7h | |
|
|
|
 | Police suspend search for teen who went missing in bizarre 'I hurt my brother' T-shirt |
| The teen went missing hours after being pictured in a bizarre T-shirt with handwritten messages reading... |
 NY Post: NYPD Blotter NY Post: NYPD Blotter | 7h | |
|
|
|
 | Shannon Sharpe ribs Scottie Pippen after ex-wife Larsa Pippen's sex reveal |
| Larsa Pippen's "Real Housewives of Miami" co-stars weren't the only ones left reeling by her recent sex... |
 NY Post: NYPD Blotter NY Post: NYPD Blotter | 7h | |
|
|
|
 | Sen. Lindsey Graham bets Al Franken $20 that Trump beats Biden in 2024 |
| Republican Sen. Lindsey Graham is putting his money on former President Donald Trump to beat incumbent... |
 NY Post: NYPD Blotter NY Post: NYPD Blotter | 7h | |
|
|
|
 | Keke Palmer shares candid 'mommying' update: 'I will never be the same again' |
| Palmer and her boyfriend, Darius Jackson, welcomed their first child, a son named Leodis, on Feb. 25... |
 NY Post: NYPD Blotter NY Post: NYPD Blotter | 7h | |
|
|
|
 | Los Angeles schools close as district workers strike |
| Schools in the Los Angeles Unified School District were closed Tuesday as tens of thousands of school... |
 NY Post: NYPD Blotter NY Post: NYPD Blotter | 7h | |
|
|
|
 | iPhone users complain Apple's autocorrect is 'ruining their lives' |
| "Not trying to sound dramatic but iPhone autocorrect is literally ruining my life," said one user furious... |
 NY Post: NYPD Blotter NY Post: NYPD Blotter | 7h | |
|
|
|
 | Kate Middleton is all business in black-and-white blazer look |
| The Princess of Wales went with trousers and an Alexander McQueen jacket as she met with executives in... |
 NY Post: NYPD Blotter NY Post: NYPD Blotter | 7h | |
|
|
|
 | Keanu Reeves honors Lance Reddick with ribbon at 'John Wick 4' premiere |
| Cast and crew received a note before the movie reading, "We kindly ask you to wear this royal blue ribbon... |
 NY Post: NYPD Blotter NY Post: NYPD Blotter | 7h | |
|
|
|
 | Town apologizes for 'sexualizing' tourism ads: 'Show us your Regina' |
| Residents were revolted by two sleazy slogans that poked fun at the fact that the city's name rhymes... |
 NY Post: NYPD Blotter NY Post: NYPD Blotter | 7h | |
|
|
|
 | Fauci, DC Mayor Muriel Bowser rejected trying to sell vax door-to-door in awkward... |
| Dr. Anthony Fauci and DC Mayor Muriel Bowser made house visits at the height of the pandemic to persuade... |
 NY Post: NYPD Blotter NY Post: NYPD Blotter | 7h | |
|
|
|
 | The Offspring, Simple Plan and Sum 41 announce 2023 tour. Get tickets now |
| The tour honestly sounds pretty fly. |
 NY Post: NYPD Blotter NY Post: NYPD Blotter | 7h | |
|
|
|
 | I'm a mechanic with 3-inch nails and heels — but my skills are the real deal |
| A model revealed she lives a double life as a mechanic — but all the men make fun of her glamorous style. |
 NY Post: NYPD Blotter NY Post: NYPD Blotter | 7h | |
|
|
|
 | Stream It Or Skip It: ‘Bono & The Edge: A Sort Of Homecoming, With Dave Letterman’... |
| In Bono & The Edge: A Sort of Homecoming, the singing and guitaring half of U2 are joined by Dave... |
 NY Post: NYPD Blotter NY Post: NYPD Blotter | 7h | |
|
|
|
 | 48 best gifts and toys for 4-year-olds in 2023, according to experts |
| We're all about the 4-year-olds — here's the only expert-backed toy guide you'll ever need. |
 NY Post: NYPD Blotter NY Post: NYPD Blotter | 7h | |
|
|
|
 | Hailey Van Lith in tense confrontation after Louisville's March Madness win over... |
| Things got chippy between Hailey Van Lith and Sonya Morris after Louisville's 73-51 win over Texas on... |
 NY Post: NYPD Blotter NY Post: NYPD Blotter | 7h | |
|
|
|
 | Bad Bunny sued by Carliz De La Cruz Hernández amid Kendall Jenner romance |
| The "Tití Me Preguntó" singer is being sued for at least $40 million over an infamous voice recording... |
 NY Post: NYPD Blotter NY Post: NYPD Blotter | 7h | |
|
|
|
 | Suffered In Silence For Many Years After A Critical Incident… And Was Then Fired. |
| My name is Adam A. Meyers and I was a Police Officer in Wisconsin for 21 years. The following article... |
 Law Enforcement Today Law Enforcement Today | 8h | |
|
|
|
| State Police Investigating Robbery of Delivery Truck Driver ... - Delaware.gov |
| State Police Investigating Robbery of Delivery Truck Driver ... Delaware.gov |
 "police" - Google News "police" - Google News | 8h | |
|
|
|
| UC Irvine Police Department commits to advancing women in law ... - UCI News |
| UC Irvine Police Department commits to advancing women in law ... UCI News |
 "police" - Google News "police" - Google News | 8h | |
|
|
|
| Jeffersonville police release bodycam footage of armed man shot by officers - WLKY... |
| Jeffersonville police release bodycam footage of armed man shot by officers WLKY Louisville |
 "police" - Google News "police" - Google News | 8h | |
|
|
|
| Amarillo Police: Armed man shot on Paramount Boulevard ... - KFDA |
| Amarillo Police: Armed man shot on Paramount Boulevard ... KFDA |
 "police" - Google News "police" - Google News | 8h | |
|
|
|
| Police searching Clinton High School after reports of shots fired - Clinton Herald |
| Police searching Clinton High School after reports of shots fired Clinton Herald |
 "police" - Google News "police" - Google News | 8h | |
|
|
|
| Police search for missing Rochester man - KTTC |
| Police search for missing Rochester man KTTC |
 "police" - Google News "police" - Google News | 8h | |
|
|
|
| Police: Man taken into custody following search in Scotlandville - WAFB |
| Police: Man taken into custody following search in Scotlandville WAFB |
 "police" - Google News "police" - Google News | 8h | |
|
|
|
| Recommendations still not implemented from 2018 Portland police gang team audit -... |
| Recommendations still not implemented from 2018 Portland police gang team audit Oregon Public Broadcasting |
 "police" - Google News "police" - Google News | 8h | |
|
|
|
| Update: Police locate allegedly abducted child, arrest mother in Daly City - CBS... |
| Update: Police locate allegedly abducted child, arrest mother in Daly City CBS News |
 "police" - Google News "police" - Google News | 8h | |
|
|
|
| Unfounded bomb threats called in against Manhattan DA, courts ... - New York Daily... |
| Unfounded bomb threats called in against Manhattan DA, courts ... New York Daily News |
 "NYPD" - Google News "NYPD" - Google News | 8h | |
|
|
|
| Bomb Threat Called In To Manhattan Civil Court |
| A bomb threat was called against a New York civil courthouse this morning, delaying proceedings while... |
 The Crime Report The Crime Report | 8h | |
|
|
|
| New police chief appointed in Pelham - WBRC |
| New police chief appointed in Pelham WBRC |
 "police" - Google News "police" - Google News | 8h | |
|
|
|
| State Police Investigating Roadside Robbery - Delaware State ... - Delaware.gov |
| State Police Investigating Roadside Robbery - Delaware State ... Delaware.gov |
 "police" - Google News "police" - Google News | 8h | |
|
|
|
| Oklahoma Post 337 provides site for local police training - The American Legion |
| Oklahoma Post 337 provides site for local police training The American Legion |
 "police" - Google News "police" - Google News | 8h | |
|
|
|
| Portland police official tried to 'mutilate' evidence to shield husband in manslaughter... |
| Portland police official tried to 'mutilate' evidence to shield husband in manslaughter case: PD Fox... |
 "police" - Google News "police" - Google News | 8h | |
|
|
|
| Police seize cache of drugs branded with photos of Mafia leaders — including... |
| Police seize cache of drugs branded with photos of Mafia leaders — including "Cosa Nostra" fugitive who... |
 "police" - Google News "police" - Google News | 8h | |
|
|
|
| Headlines - Police Press Release - March 21, 2023 - Anne Arundel County |
| Headlines - Police Press Release - March 21, 2023 Anne Arundel County |
 "police" - Google News "police" - Google News | 8h | |
|
|
|
| Police arrest 18-year-old man for West Lafayette shooting in ... - Journal & Courier |
| Police arrest 18-year-old man for West Lafayette shooting in ... Journal & Courier |
 "police" - Google News "police" - Google News | 8h | |
|
|
|
| Group of kids stop man from kidnapping student at Maryland school bus stop, police... |
| Group of kids stop man from kidnapping student at Maryland school bus stop, police say NBC News |
 "police" - Google News "police" - Google News | 8h | |
|
|
|
| Toddler dies after dad takes her from day care and leads cops on chase, Texas police... |
| Toddler dies after dad takes her from day care and leads cops on chase, Texas police say Fort Worth... |
 "police" - Google News "police" - Google News | 8h | |
|
|
|
| WV state police leader resigns; death of man on I-81 part of probe - Herald-Mail... |
| WV state police leader resigns; death of man on I-81 part of probe Herald-Mail Media |
 "police" - Google News "police" - Google News | 8h | |
|
|
|
| Westfield police officer hospitalized after getting hit by car Tuesday - MassLive.com |
| Westfield police officer hospitalized after getting hit by car Tuesday MassLive.com |
 "police" - Google News "police" - Google News | 8h | |
|
|
|
| Police: KFC manager stole nearly $12K from Naugatuck restaurant - CT Insider |
| Police: KFC manager stole nearly $12K from Naugatuck restaurant CT Insider |
 "police" - Google News "police" - Google News | 8h | |
|
|
|
| 'It's cutting edge': Warner Robins Police looking to access your security cameras... |
| 'It's cutting edge': Warner Robins Police looking to access your security cameras for new safety initiative 13WMAZ.com |
 "police" - Google News "police" - Google News | 8h | |
|
|
|
| Cuyahoga County executive considers funding for police social workers - Cleveland... |
| Cuyahoga County executive considers funding for police social workers Cleveland 19 News |
 "police" - Google News "police" - Google News | 8h | |
|
|
|
| NYPD, Secret Service prepare for possible unrest if Trump is indicted - FISM TV |
| NYPD, Secret Service prepare for possible unrest if Trump is indicted FISM TV |
 "NYPD" - Google News "NYPD" - Google News | 8h | |
|
|
|
| Two cop cars set ablaze in NYC's Flatiron District; NYPD hunt arsonist - msnNOW |
| Two cop cars set ablaze in NYC's Flatiron District; NYPD hunt arsonist msnNOW |
 "NYPD" - Google News "NYPD" - Google News | 8h | |
|
|
|
| Two new candidates preparing to join incumbent returning to ... - Chicago Tribune |
| Two new candidates preparing to join incumbent returning to ... Chicago Tribune |
 "Robb Elementary Uvalde" - Google News "Robb Elementary Uvalde" - Google News | 8h | |
|
|
|
| After Arlington shooting, how can Texas schools prevent crime outside their buildings?... |
| After Arlington shooting, how can Texas schools prevent crime outside their buildings? Yahoo News |
 "Robb Elementary Uvalde" - Google News "Robb Elementary Uvalde" - Google News | 8h | |
|
|
|
 | Selected Articles Review at 11 a.m. - Putin sticks to protocol during Chinese leader... |
| ... |
 The News And Times The News And Times | 9h | |
|
|
|
| Braverman accused of 'dangerous' complacency in tackling police failings - The Guardian |
| Braverman accused of 'dangerous' complacency in tackling police failings The Guardian |
 "police" - Google News "police" - Google News | 9h | |
|
|
|
| New Haven chief to give update on investigation into man's police custody paralysis... |
| New Haven chief to give update on investigation into man's police custody paralysis case Eyewitness... |
 "police" - Google News "police" - Google News | 9h | |
|
|
|
| *Update - One Suspect Arrested* Delaware State Police ... - Delaware.gov |
| *Update - One Suspect Arrested* Delaware State Police ... Delaware.gov |
 "police" - Google News "police" - Google News | 9h | |
|
|
|
| Man injured in Middleton shooting dies; police say shooting stemmed from vehicle... |
| Man injured in Middleton shooting dies; police say shooting stemmed from vehicle purchase Channel3000.com... |
 "police" - Google News "police" - Google News | 9h | |
|
|
|
| Clinton High School cancels school as police investigate report of possible gunshots... |
| Clinton High School cancels school as police investigate report of possible gunshots KCRG |
 "police" - Google News "police" - Google News | 9h | |
|
|
|
| Book Review: 'Walk the Walk,' by Neil Gross - The New York Times |
| Book Review: 'Walk the Walk,' by Neil Gross The New York Times |
 "police" - Google News "police" - Google News | 9h | |
|
|
|
| Morning Roundup: Police say Butler County woman arrested in fatal ... - TribLIVE |
| Morning Roundup: Police say Butler County woman arrested in fatal ... TribLIVE |
 "police" - Google News "police" - Google News | 9h | |
|
|
|
| Police investigating overnight homicide in North City - KMOV4 |
| Police investigating overnight homicide in North City KMOV4 |
 "police" - Google News "police" - Google News | 9h | |
|
|
|
| Police ID Antioch Man Suspected of Stabbing Pregnant Woman, Kids - NBC Bay Area |
| Police ID Antioch Man Suspected of Stabbing Pregnant Woman, Kids NBC Bay Area |
 "police" - Google News "police" - Google News | 9h | |
|
|
|
| West Virginia state police superintendent resigns amid probe - The Associated Press |
| West Virginia state police superintendent resigns amid probe The Associated Press |
 "police" - Google News "police" - Google News | 9h | |
|
|
|
| Two sex offenders jailed; El Cajon police seek to ID potential ... - The San Diego... |
| Two sex offenders jailed; El Cajon police seek to ID potential ... The San Diego Union-Tribune |
 "police" - Google News "police" - Google News | 9h | |
|
|
|
| Teen allegedly smoking marijuana pepper-sprayed man, 70, in NYC building: NYPD -... |
| Teen allegedly smoking marijuana pepper-sprayed man, 70, in NYC building: NYPD PIX11 New York News |
 "NYPD" - Google News "NYPD" - Google News | 9h | |
|
|
|
| Texas Standard for March 21, 2023: Indigenous chefs take center ... - Texas Standard |
| Texas Standard for March 21, 2023: Indigenous chefs take center ... Texas Standard |
 "Robb Elementary Uvalde" - Google News "Robb Elementary Uvalde" - Google News | 9h | |
|
|
|
| How Delaware school death threat worsened rift between police ... - The News Journal |
| How Delaware school death threat worsened rift between police ... The News Journal |
 "Robb Elementary Uvalde" - Google News "Robb Elementary Uvalde" - Google News | 9h | |
|
|
|
| Assembly Bill increases age to buy semi-automatic weapon in Nevada - KOLO |
| Assembly Bill increases age to buy semi-automatic weapon in Nevada KOLO |
 "Robb Elementary Uvalde" - Google News "Robb Elementary Uvalde" - Google News | 9h | |
|
|
|
| Biden Vetoes Anti-ESG Bill, Accomplishing the Barest of Minimums ... - The New Republic |
| Biden Vetoes Anti-ESG Bill, Accomplishing the Barest of Minimums ... The New Republic |
 "Robb Elementary Uvalde" - Google News "Robb Elementary Uvalde" - Google News | 9h | |
|
|
|
| Days After Biden Approves Willow, IPCC Says That Current Fossil ... - The New Republic |
| Days After Biden Approves Willow, IPCC Says That Current Fossil ... The New Republic |
 "Robb Elementary Uvalde" - Google News "Robb Elementary Uvalde" - Google News | 9h | |
|
|
|
 | The Trial That Upset Me Most | Crime Scene Reporting with Kevin Sheehan |
| Long Island stepmom Angela Pollina was found guilty of all counts in the murder trial of 8-year-old Thomas... |
 NY Post: NYPD Blotter NY Post: NYPD Blotter | 9h | |
|
|
|
 | We reviewed 17 top hair sprays for the best all-day hold in 2023 |
| Finally! The answer to your question: "what's a great hairspray that'll *actually* last?" |
 NY Post: NYPD Blotter NY Post: NYPD Blotter | 9h | |
|
|
|
 | Padma Lakshmi and daughter Krishna, 13, match in glamorous black gowns |
| On Monday, the "Top Chef" host and her teen daughter, Krishna Thea Lakshmi-Dell, coordinated in LBDs... |
 NY Post: NYPD Blotter NY Post: NYPD Blotter | 9h | |
|
|
|
 | Influencer Bella Varelis roasted after complaining about rent increase: 'Get a real... |
| Bella Varelis forged a career as an influencer after coming in second place on Network 10's eighth season... |
 NY Post: NYPD Blotter NY Post: NYPD Blotter | 9h | |
|
|
|
 | Credit Suisse rescue could reportedly spur 'tens of thousands' of layoffs |
| The culling is expected to hit hardest at Credit Suisse's operations in Switzerland and its investment... |
 NY Post: NYPD Blotter NY Post: NYPD Blotter | 9h | |
|
|
|
 | Prince Andrew is trying to 'worm his way' back into royal life, deserves 'boot' |
| "The only order he should be given is the order of the boot," said ex-MP Norman Baker, accusing Andrew... |
 NY Post: NYPD Blotter NY Post: NYPD Blotter | 9h | |
|
|
|
 | 'Simpsons' fans furious at plot hole in character's return after 33 years |
| Fans of the long-running animated comedy "The Simpsons" are furious at a plot hole involving a season... |
 NY Post: NYPD Blotter NY Post: NYPD Blotter | 9h | |
|
|
|
 | March Madness 2023 odds: Reseeding the NCAA Tournament Sweet 16 teams |
| From 64 to 16, and eventually, there will only be one. |
 NY Post: NYPD Blotter NY Post: NYPD Blotter | 9h | |
|
|
|
 | Dream away this spring with $34 luxury bed sheets |
| Bamboo for you, for less. |
 NY Post: NYPD Blotter NY Post: NYPD Blotter | 9h | |
|
|
|
 | Kieran Culkin locks lips with wife Jazz Charton at 'Succession' premiere |
| The actor and the former model didn't shy away from showing PDA while walking the red carpet in New York... |
 NY Post: NYPD Blotter NY Post: NYPD Blotter | 9h | |
|
|
|
 | The 10 best places to order Asian groceries and food delivery online |
| Add some culinary stamps to your cooking passport with these Asian groceries |
 NY Post: NYPD Blotter NY Post: NYPD Blotter | 9h | |
|
|
|
 | Justin Thomas signs chest of OnlyFans model Karin Hart: 'Made my year' |
| When competing in this weekend's PGA Tour event in Florida, the two-time major champion was asked to... |
 NY Post: NYPD Blotter NY Post: NYPD Blotter | 9h | |
|
|
|
 | Virginia teacher Abigail Zwerner shot by 6-year-old still has bullet lodged in her... |
| Abigail Zwerner, 25, sat down this week with "Today's" Savannah Guthrie for her first-ever interview. |
 NY Post: NYPD Blotter NY Post: NYPD Blotter | 9h | |
|
|
|
 | Shaquille O'Neal jokes he got a BBL after stressing out fans with hospital photo |
| The NBA legend told his Twitter followers that they have "no need to worry" after he posted a photo in... |
 NY Post: NYPD Blotter NY Post: NYPD Blotter | 9h | |
|
|
|
 | Nick Saban appears to shade Nate Oats after kicking Alabama football player off team |
| It appears we have some Alabama-on-Alabama shade being thrown. |
 NY Post: NYPD Blotter NY Post: NYPD Blotter | 9h | |
|
|
|
 | 'Summer House' star Ciara Miller is Bravo's first Victoria's Secret model |
| "It's been a dream for as long as I can remember to work for Victoria's Secret," Miller tells Page Six... |
 NY Post: NYPD Blotter NY Post: NYPD Blotter | 9h | |
|
|
|
 | 'RuPaul's Drag Race' EPs on Fighting "Misguided" Attacks on Drag: "We Cannot Ignore... |
| Fenton Bailey and Randy Barbato break down Drag Race's partnership with the ACLU for the Drag Defense... |
 NY Post: NYPD Blotter NY Post: NYPD Blotter | 9h | |
|
|
|
 | Star high school athletes killed in spring break sledding accident at ski resort |
| Dylan Bazzell and Drew Fehr, of Illinois, were killed in a sledding accident on Sunday night. |
 NY Post: NYPD Blotter NY Post: NYPD Blotter | 9h | |
|
|
|
 | Taylor Swift leaves fans speechless after diving headfirst into stage gap |
| Taylor Swift amazed fans after diving headfirst into the stage during her Eras Tour. |
 NY Post: NYPD Blotter NY Post: NYPD Blotter | 9h | |
|
|
|
 | 'Wheel of Fortune' Fans Claim "Unfair Terminology" Caused One Contestant's Loss:... |
| The stumped contestant lost out on an additional $40,000. |
 NY Post: NYPD Blotter NY Post: NYPD Blotter | 9h | |
|
|
|
 | |
| Michael Novakhov retweeted: This CIA doctor's team investigated the mysterious... |
 Tweets by @mikenov Tweets by @mikenov | 9h | |
|
|
|
 | |
| Putin and Xi Jinping - 10:05 AM 3/21/2023 thenewsandtimes.blogspot.com/2023/03/putin-… |
 Tweets by @mikenov Tweets by @mikenov | 9h | |
|
|
|
| Retired Hartford Police Chief Loranger Has Died at 83 - NBC Connecticut |
| Retired Hartford Police Chief Loranger Has Died at 83 NBC Connecticut |
 "police" - Google News "police" - Google News | 9h | |
|
|
|
| U.S. Marshals capture three people after police chase, crash in Jackson - WLBT |
| U.S. Marshals capture three people after police chase, crash in Jackson WLBT |
 "police" - Google News "police" - Google News | 9h | |
|
|
|
| Hermitage Police describe murder suspect as 'armed and dangerous' - WFMJ |
| Hermitage Police describe murder suspect as 'armed and dangerous' WFMJ |
 "police" - Google News "police" - Google News | 9h | |
|
|
|
| Police: Missing 17-year-old from Coram found safe - News 12 Long Island |
| Police: Missing 17-year-old from Coram found safe News 12 Long Island |
 "police" - Google News "police" - Google News | 9h | |
|
|
|
| Westmoreland road reopens after police activity causes closure - WPXI Pittsburgh |
| Westmoreland road reopens after police activity causes closure WPXI Pittsburgh |
 "police" - Google News "police" - Google News | 9h | |
|
|
|
| Indiana police continue dayslong search for missing 14-year-old believed to be in... |
| Indiana police continue dayslong search for missing 14-year-old believed to be in 'extreme danger' Fox... |
 "police" - Google News "police" - Google News | 9h | |
|
|
|
| Robbers Target Astoria, Jamaica Straphangers On NYC Train: NYPD - Patch.com |
| Robbers Target Astoria, Jamaica Straphangers On NYC Train: NYPD Patch.com |
 "NYPD" - Google News "NYPD" - Google News | 9h | |
|
|
|
| Groper Follows Woman Into West Village Home: NYPD - Patch |
| Groper Follows Woman Into West Village Home: NYPD Patch |
 "NYPD" - Google News "NYPD" - Google News | 9h | |
|
|
|
 | Putin and Xi Jinping - 10:05 AM 3/21/2023 |
| Putin and Xi Jinping - 10:05 AM 3/21/2023Ukraine war live updates: Russian mercenaries say Kyiv is preparing... |
 The News And Times The News And Times | 9h | |
|
|
|
| Trump Expects Arrest on Stormy Daniels Payout Charges, City Prepares for Protests |
| Over the weekend, former President Donald Trump took to social media and announced he expected to be... |
 The Crime Report The Crime Report | 10h | |
|
|
|
| OKC police assisting US Marshals in search for escaped inmate, prompts large police... |
| OKC police assisting US Marshals in search for escaped inmate, prompts large police presence KOCO Oklahoma... |
 "police" - Google News "police" - Google News | 10h | |
|
|
|
| Springs police looking for missing 13-year-old girl - KKTV |
| Springs police looking for missing 13-year-old girl KKTV |
 "police" - Google News "police" - Google News | 10h | |
|
|
|
| Highland Police Blotter, March 22 - Belleville News-Democrat |
| Highland Police Blotter, March 22 Belleville News-Democrat |
 "police" - Google News "police" - Google News | 10h | |
|
|
|
| Victim identified in deadly Richmond shooting, police still investigating - WRIC... |
| Victim identified in deadly Richmond shooting, police still investigating WRIC ABC 8News |
 "police" - Google News "police" - Google News | 10h | |
|
|
|
| Shooting Suspect in Custody After Police Chase Ends With Crash in SW Miami-Dade -... |
| Shooting Suspect in Custody After Police Chase Ends With Crash in SW Miami-Dade NBC 6 South Florida |
 "police" - Google News "police" - Google News | 10h | |
|
|
|
| State police investigating deadly shooting in Butler County - CBS Pittsburgh |
| State police investigating deadly shooting in Butler County CBS Pittsburgh |
 "police" - Google News "police" - Google News | 10h | |
|
|
|
| Police looking for 3 men involved in armed robbery - 14 News WFIE Evansville |
| Police looking for 3 men involved in armed robbery 14 News WFIE Evansville |
 "police" - Google News "police" - Google News | 10h | |
|
|
|
| Police investigating overnight smash-and-grab attempt at Lake Ave. Dunkin' Donuts... |
| Police investigating overnight smash-and-grab attempt at Lake Ave. Dunkin' Donuts 13WHAM-TV |
 "police" - Google News "police" - Google News | 10h | |
|
|
|
| Judge orders DA to release records in Anthony Harden police ... - Fall River Herald... |
| Judge orders DA to release records in Anthony Harden police ... Fall River Herald News |
 "police" - Google News "police" - Google News | 10h | |
|
|
|
| Police arrest man accused of stealing van, body from funeral home - WMTV – NBC15 |
| Police arrest man accused of stealing van, body from funeral home WMTV – NBC15 |
 "police" - Google News "police" - Google News | 10h | |
|
|
|
| Police searching for missing 18-year-old Union woman - LINK nky |
| Police searching for missing 18-year-old Union woman LINK nky |
 "police" - Google News "police" - Google News | 10h | |
|
|
|
| 70-year-old Chelsea man pepper-sprayed after asking pot-smoking ... - AMNY |
| 70-year-old Chelsea man pepper-sprayed after asking pot-smoking ... AMNY |
 "NYPD" - Google News "NYPD" - Google News | 10h | |
|
|
|
| Man Gropes Woman After Following Her To West Village Home: NYPD - Patch.com |
| Man Gropes Woman After Following Her To West Village Home: NYPD Patch.com |
 "NYPD" - Google News "NYPD" - Google News | 10h | |
|
|
|
| NYC Public Defenders Request Funding Bump To Tackle Staffing Crisis |
| The six major public defender groups in New York City that provide free representation in criminal and... |
 The Crime Report The Crime Report | 10h | |
|
|
|
| 'Walking the Walk' Webinar To Discuss Police Culture |
| Later today: Eric Jones, former Police Chief for Stockton and current Deputy Executive of Public Safety... |
 The Crime Report The Crime Report | 10h | |
|
|
|
| Colorado Bill To Incentivize Prison Education With Sentence Reductions |
| Last Friday, Colorado lawmakers passed a bill that would reduce prison sentences for incarcerated people... |
 The Crime Report The Crime Report | 10h | |
|
|
|
| Florida Man Arrested For Aggravated Battery Allegedly Ranted About The Jewish Officer... |
| A Florida man accused of intentionally hit bicyclists with his car and apparently targeted, among others,... |
 The Crime Report The Crime Report | 10h | |
|
|
|
| Paralyzed Court: Are NY Courts Stagnant Without A Chief Judge In The Court of Appeals? |
| The New York City judiciary has been weathering an extended period without a chief judge, which has caused... |
 The Crime Report The Crime Report | 10h | |
|
|
|
| Ericsson 'Impaired' DOJ Investigation. Did It Get Off Easy? |
| Ericsson, a Swedish telecoms company, allegedly hid potential bribery scheme records in safes and basement... |
 The Crime Report The Crime Report | 10h | |
|
|
|
| Man accused of crashing into child's bedroom while driving drunk, police say - WMTV... |
| Man accused of crashing into child's bedroom while driving drunk, police say WMTV – NBC15 |
 "police" - Google News "police" - Google News | 10h | |
|
|
|
| Retail Theft Investigation; WT-23-02885 | Warminster Township ... - Bucks County... |
| Retail Theft Investigation; WT-23-02885 | Warminster Township ... Bucks County | CRIMEWATCH PA |
 "police" - Google News "police" - Google News | 10h | |
|
|
|
| Likud MK warns police chief, citizens could face probes, prosecution ... - The Times... |
| Likud MK warns police chief, citizens could face probes, prosecution ... The Times of Israel |
 "police" - Google News "police" - Google News | 10h | |
|
|
|
| Officials: Bus routes suspended as police search for man - WAFB |
| Officials: Bus routes suspended as police search for man WAFB |
 "police" - Google News "police" - Google News | 10h | |
|
|
|
| Waterford police investigating person of interest after 2 car fires - FOX 2 Detroit |
| Waterford police investigating person of interest after 2 car fires FOX 2 Detroit |
 "police" - Google News "police" - Google News | 10h | |
|
|
|
| Police: Thief wanted for stealing eggs, money from roadside coolers of Bucks County... |
| Police: Thief wanted for stealing eggs, money from roadside coolers of Bucks County neighbors FOX 29... |
 "police" - Google News "police" - Google News | 10h | |
|
|
|
| Springfield Police investigate shooting on Memorial Boulevard - WSMV 4 |
| Springfield Police investigate shooting on Memorial Boulevard WSMV 4 |
 "police" - Google News "police" - Google News | 10h | |
|
|
|
| Route 119 in East Huntingdon Township reopens after police investigation - WTAE Pittsburgh |
| Route 119 in East Huntingdon Township reopens after police investigation WTAE Pittsburgh |
 "police" - Google News "police" - Google News | 10h | |
|
|
|
| Calif. city pays $750,000 after police allegedly paint swastika in car - The Washington... |
| Calif. city pays $750,000 after police allegedly paint swastika in car The Washington Post |
 "police" - Google News "police" - Google News | 10h | |
|
|
|
| Video captures moment tractor-trailer slams into New Jersey police vehicles - WPVI-TV |
| Video captures moment tractor-trailer slams into New Jersey police vehicles WPVI-TV |
 "police" - Google News "police" - Google News | 10h | |
|
|
|
| Pueblo police say fentanyl remains big problem following discovery of drug hidden... |
| Pueblo police say fentanyl remains big problem following discovery of drug hidden inside stuffed animal KKTV |
 "police" - Google News "police" - Google News | 10h | |
|
|
|
| Police search for woman who triggered Amber Alert on Sunday night - Lewiston Sun... |
| Police search for woman who triggered Amber Alert on Sunday night Lewiston Sun Journal |
 "police" - Google News "police" - Google News | 10h | |
|
|
|
| 3 sought in connection to armed robbery at Brooklyn deli: NYPD - PIX11 New York News |
| 3 sought in connection to armed robbery at Brooklyn deli: NYPD PIX11 New York News |
 "NYPD" - Google News "NYPD" - Google News | 10h | |
|
|
|
| Crooks put man in headlock in Queens train platform robbery: NYPD - PIX11 New York... |
| Crooks put man in headlock in Queens train platform robbery: NYPD PIX11 New York News |
 "NYPD" - Google News "NYPD" - Google News | 10h | |
|
|
|
 | China's Xi invites 'dear friend' Putin to visit |
| Chinese President Xi Jinping invited his "dear friend" Russian President Vladimir Putin to visit China... |
 NY Post: NYPD Blotter NY Post: NYPD Blotter | 10h | |
|
|
|
 | Haley Cavinder shushes Indiana fans after clutch free throws in Miami's March Madness... |
| With a Sweet 16 berth just seconds away, Miami's Haley Cavinder got flashy. |
 NY Post: NYPD Blotter NY Post: NYPD Blotter | 10h | |
|
|
|
 | Zach Shallcross Messed Up 'The Bachelor's "Sex Week" So Spectacularly, It Turned... |
| Ladies, dump this man! |
 NY Post: NYPD Blotter NY Post: NYPD Blotter | 10h | |
|
|
|
 | Georgia college student Jordan Idahosa killed in Miami spring break violence |
| One of the men killed when gunfire erupted during spring break in Miami Beach has been identified as... |
 NY Post: NYPD Blotter NY Post: NYPD Blotter | 10h | |
|
|
|
 | Where these loaded Rangers fit in the pantheon of all-time best line groups |
| As potent as these Rangers have become, what kind of chance do they have to measure up to some of the... |
 NY Post: NYPD Blotter NY Post: NYPD Blotter | 10h | |
|
|
|
 | Amanda Bynes' family not considering conservatorship amid psych hold: report |
| The former "Amanda Show" star's eight-year conservatorship ended in March 2022. At the time, her attorney... |
 NY Post: NYPD Blotter NY Post: NYPD Blotter | 10h | |
|
|
|
 | Why a 1 percent chance of winning the NBA title feels like a lot more for these Knicks... |
| With the Knicks entering their final nine games of the regular season, one popular simulation gives them... |
 NY Post: NYPD Blotter NY Post: NYPD Blotter | 10h | |
|
|
|
 | Keanu Reeves gets emotional over how much Lance Reddick's death 'f–king sucks' |
| "He was a beautiful person, a special artist [and] a man of grace and dignity," Reeves gushed of the... |
 NY Post: NYPD Blotter NY Post: NYPD Blotter | 10h | |
|
|
|
 | Inside the 'cult' that fooled Newark into being sister cities with a fake nation |
| Kailasa attained Sister City status with Newark, NJ -- until city leaders discovered that Kailasa does... |
 NY Post: NYPD Blotter NY Post: NYPD Blotter | 10h | |
|
|
|
| U.K.'s Biggest Police Force Is Institutionally Sexist, Racist And Homophobic, Report... |
| U.K.'s Biggest Police Force Is Institutionally Sexist, Racist And Homophobic, Report Finds Forbes |
 "police" - Google News "police" - Google News | 11h | |
|
|
|
| Los Angeles police accidentally release photos of undercover ... - Los Angeles Times |
| Los Angeles police accidentally release photos of undercover ... Los Angeles Times |
 "police" - Google News "police" - Google News | 11h | |
|
|
|
| Art Fraud Doc Shocker: Filmmaker Fights to Keep Source Material After Police Seize... |
| Art Fraud Doc Shocker: Filmmaker Fights to Keep Source Material After Police Seize Raw Footage In Major... |
 "police" - Google News "police" - Google News | 11h | |
|
|
|
| CAUGHT ON CAMERA: Stolen Amazon truck chased by police - Live 5 News WCSC |
| CAUGHT ON CAMERA: Stolen Amazon truck chased by police Live 5 News WCSC |
 "police" - Google News "police" - Google News | 11h | |
|
|
|
| Police arrest man accused of stealing van, body from funeral home - KAIT |
| Police arrest man accused of stealing van, body from funeral home KAIT |
 "police" - Google News "police" - Google News | 11h | |
|
|
|
| VT Police search for armed robber - WDBJ |
| VT Police search for armed robber WDBJ |
 "police" - Google News "police" - Google News | 11h | |
|
|
|
| Police: 2 inmates taken into custody after escape from Newport ... - WAVY.com |
| Police: 2 inmates taken into custody after escape from Newport ... WAVY.com |
 "police" - Google News "police" - Google News | 11h | |
|
|
|
| Body cam shows suspect spitting on OKC police officers multiple times during arrest... |
| Body cam shows suspect spitting on OKC police officers multiple times during arrest KFOR Oklahoma City |
 "police" - Google News "police" - Google News | 11h | |
|
|
|
| Predatory pricing: What you don't know about police towing could wreck your wallet... |
| Predatory pricing: What you don't know about police towing could wreck your wallet | Opinion Wichita... |
 "police" - Google News "police" - Google News | 11h | |
|
|
|
| West Virginia state police superintendent resigns amid probe - Yahoo News |
| West Virginia state police superintendent resigns amid probe Yahoo News |
 "police" - Google News "police" - Google News | 11h | |
|
|
|
| Justice to announce results of State Police investigation, Cahill resigns - Parkersburg... |
| Justice to announce results of State Police investigation, Cahill resigns Parkersburg News |
 "police" - Google News "police" - Google News | 11h | |
|
|
|
| |
| news.google.com/rss/articles/C… |
 Tweets by @mikenov Tweets by @mikenov | 11h | |
|
|
|
| Police search for mother after newborn found abandoned outside Springfield home -... |
| Police search for mother after newborn found abandoned outside Springfield home The Boston Globe |
 "police" - Google News "police" - Google News | 11h | |
|
|
|
| Police: Fight leads to gunshots, property damage, no injuries at Cedar Rapids bar... |
| Police: Fight leads to gunshots, property damage, no injuries at Cedar Rapids bar KCRG |
 "police" - Google News "police" - Google News | 11h | |
|
|
|
| Man found 'burned beyond recognition' in deadly Strawberry Mansion fire, police say... |
| Man found 'burned beyond recognition' in deadly Strawberry Mansion fire, police say FOX 29 Philadelphia |
 "police" - Google News "police" - Google News | 11h | |
|
|
|
| Police records show increase in violence, threats at Central ... - Asbury Park Press |
| Police records show increase in violence, threats at Central ... Asbury Park Press |
 "police" - Google News "police" - Google News | 11h | |
|
|
|
| Driver on I-94 'tries to avoid' police, runs out of gas, falls down while ... - WDIV... |
| Driver on I-94 'tries to avoid' police, runs out of gas, falls down while ... WDIV ClickOnDetroit |
 "police" - Google News "police" - Google News | 12h | |
|
|
|
| Traffic alert: Police pursuit ends with crash on Don Shula ... - WPLG Local 10 |
| Traffic alert: Police pursuit ends with crash on Don Shula ... WPLG Local 10 |
 "police" - Google News "police" - Google News | 12h | |
|
|
|
| Poll: How much do you trust your local police force? - Yahoo! Voices |
| Poll: How much do you trust your local police force? Yahoo! Voices |
 "police" - Google News "police" - Google News | 12h | |
|
|
|
| Police looking for 3 men involved in armed robbery - 14 News WFIE Evansville |
| Police looking for 3 men involved in armed robbery 14 News WFIE Evansville |
 "police" - Google News "police" - Google News | 12h | |
|
|
|
| London police institutionally racist and sexist, report finds - Reuters.com |
| London police institutionally racist and sexist, report finds Reuters.com |
 "police" - Google News "police" - Google News | 12h | |
|
|
|
| State of Ohio investigating former police officer for criminal conduct with a minor... |
| State of Ohio investigating former police officer for criminal conduct with a minor WTOL |
 "police" - Google News "police" - Google News | 12h | |
|
|
|
| Wylie man arrested, accused of continuous sexual assault of child - The Dallas Morning... |
| Wylie man arrested, accused of continuous sexual assault of child The Dallas Morning News |
 "police" - Google News "police" - Google News | 12h | |
|
|
|
| Indiana bill would help provide police bleeding control kits - FOX 59 Indianapolis |
| Indiana bill would help provide police bleeding control kits FOX 59 Indianapolis |
 "police" - Google News "police" - Google News | 12h | |
|
|
|
| Police: Two local men arrested after pointing guns at local women ... - Idaho State... |
| Police: Two local men arrested after pointing guns at local women ... Idaho State Journal |
 "police" - Google News "police" - Google News | 12h | |
|
|
|
| Local police pursuit ends on railroad tracks - WKBN.com |
| Local police pursuit ends on railroad tracks WKBN.com |
 "police" - Google News "police" - Google News | 12h | |
|
|
|
| El Paso police arrest two 14-year-olds in connection to Circle K robberies - KFOX... |
| El Paso police arrest two 14-year-olds in connection to Circle K robberies KFOX El Paso |
 "police" - Google News "police" - Google News | 12h | |
|
|
|
| Justice Jackson Challenges Trend Of Specially Vacated Decisions In Supreme Court |
| There are a few interesting things out of the orders from last week's private U.S. Supreme Court conference,... |
 The Crime Report The Crime Report | 12h | |
|
|
|
| Ahmaud Arbery's Killers Are Appealing Their Federal Hate Crime Convictions |
| Did the men who followed and shot a jogger in Georgia target and kill him because he was Black, or as... |
 The Crime Report The Crime Report | 12h | |
|
|
|
 | Rick Pitino celebrates becoming new St. John's coach with toast at Manhattan hotel |
| Rick Pitino was the toast of the town on Monday, and he did exactly that after accepting the St. John's... |
 NY Post: NYPD Blotter NY Post: NYPD Blotter | 12h | |
|
|
|
 | Stormy Daniels beefs up security over death threats in Trump case |
| "Had so many orders come in today!" the porn star tweeted, while her lawyer said she has had to beef... |
 NY Post: NYPD Blotter NY Post: NYPD Blotter | 12h | |
|
|
|
 | Chris Hemsworth, wife Elsa slammed over 'violent' birthday prank on son |
| The "Thor" actor and his wife, Elsa Pataky, have found themselves in hot water after sharing a birthday... |
 NY Post: NYPD Blotter NY Post: NYPD Blotter | 12h | |
|
|
|
 | Nick Cannon says ex-wife Mariah Carey is 'not human' |
| The comedian, who recently welcomed his 12th child in December, said the "We Belong Together" hitmaker... |
 NY Post: NYPD Blotter NY Post: NYPD Blotter | 12h | |
|
|
|
 | 63-year-old kidnapping victim escapes trunk after car crashes into home |
| When officers arrived on the scene just after 5 a.m., witnesses reported a man claiming he had been kidnapped... |
 NY Post: NYPD Blotter NY Post: NYPD Blotter | 12h | |
|
|
|
| Police chase ends in crash on I-565 off-ramp near Bob Wallace Ave. - WAFF |
| Police chase ends in crash on I-565 off-ramp near Bob Wallace Ave. WAFF |
 "police" - Google News "police" - Google News | 12h | |
|
|
|
| Cambridge City Council Contemplates Police Body Cameras ... - Harvard Crimson |
| Cambridge City Council Contemplates Police Body Cameras ... Harvard Crimson |
 "police" - Google News "police" - Google News | 12h | |
|
|
|
| Bus driver, police officers injured after suspect barricades on bus in southwest... |
| Bus driver, police officers injured after suspect barricades on bus in southwest Las Vegas News3LV |
 "police" - Google News "police" - Google News | 12h | |
|
|
|
| City police calls – March 21 - The Republic |
| City police calls – March 21 The Republic |
 "police" - Google News "police" - Google News | 12h | |
|
|
|
| Essex Police Department introduces new Citizen Police Academy Program - WPTZ |
| Essex Police Department introduces new Citizen Police Academy Program WPTZ |
 "police" - Google News "police" - Google News | 13h | |
|
|
|
| Police reports | News, Sports, Jobs - The Daily Times |
| Police reports | News, Sports, Jobs The Daily Times |
 "police" - Google News "police" - Google News | 13h | |
|
|
|
| Atlanta police monitoring possible protests ahead of anticipated ... - FOX 5 Atlanta |
| Atlanta police monitoring possible protests ahead of anticipated ... FOX 5 Atlanta |
 "police" - Google News "police" - Google News | 13h | |
|
|
|
| Police arrest suspect in fatal Sheridan Street beating - Honolulu Star-Advertiser |
| Police arrest suspect in fatal Sheridan Street beating Honolulu Star-Advertiser |
 "police" - Google News "police" - Google News | 13h | |
|
|
|
| Suspect disposed of missing Georgia man's body, police say - WMTV – NBC15 |
| Suspect disposed of missing Georgia man's body, police say WMTV – NBC15 |
 "police" - Google News "police" - Google News | 13h | |
|
|
|
| CAUGHT ON CAMERA: Stolen Amazon truck chased by police - WABI |
| CAUGHT ON CAMERA: Stolen Amazon truck chased by police WABI |
 "police" - Google News "police" - Google News | 13h | |
|
|
|
| Police: 3 suspects robbed victim, opened fire near crowded West Oahu beach - Hawaii... |
| Police: 3 suspects robbed victim, opened fire near crowded West Oahu beach Hawaii News Now |
 "police" - Google News "police" - Google News | 13h | |
|
|
|
| Alabama freshman DB Tony Mitchell attempted to flee at 141 mph: police - New York... |
| Alabama freshman DB Tony Mitchell attempted to flee at 141 mph: police New York Post |
 "police" - Google News "police" - Google News | 13h | |
|
|
|
| Antioch police identify man suspected in stabbing of pregnant woman, kids - CBS San... |
| Antioch police identify man suspected in stabbing of pregnant woman, kids CBS San Francisco |
 "police" - Google News "police" - Google News | 13h | |
|
|
|
| NYPD sets up barricades near Manhattan court ahead of possible Trump indictment -... |
| NYPD sets up barricades near Manhattan court ahead of possible Trump indictment AOL |
 "NYPD" - Google News "NYPD" - Google News | 13h | |
|
|
|
| Police: Fight leads to deadly shooting inside Overbrook bar - FOX 29 Philadelphia |
| Police: Fight leads to deadly shooting inside Overbrook bar FOX 29 Philadelphia |
 "police" - Google News "police" - Google News | 13h | |
|
|
|
| CAUGHT ON CAMERA: Stolen Amazon truck chased by police - WMTV – NBC15 |
| CAUGHT ON CAMERA: Stolen Amazon truck chased by police WMTV – NBC15 |
 "police" - Google News "police" - Google News | 13h | |
|
|
|
| Area Police Reports | News, Sports, Jobs - Jamestown Post Journal |
| Area Police Reports | News, Sports, Jobs Jamestown Post Journal |
 "police" - Google News "police" - Google News | 13h | |
|
|
|
| Cleveland City Council approves plans for new police HQ - cleveland.com |
| Cleveland City Council approves plans for new police HQ cleveland.com |
 "police" - Google News "police" - Google News | 13h | |
|
|
|
| Police seize guns during East Side raid | Local News | ncnewsonline ... - New Castle... |
| Police seize guns during East Side raid | Local News | ncnewsonline ... New Castle News |
 "police" - Google News "police" - Google News | 13h | |
|
|
|
| Driver arrested in wild Brooklyn crash that left 2 dead: police - PIX11 New York... |
| Driver arrested in wild Brooklyn crash that left 2 dead: police PIX11 New York News |
 "NYPD" - Google News "NYPD" - Google News | 13h | |
|
|
|
 | Horror as monster snake discovered in bed |
| The warning came after an enormous brown snake had to be removed from someone's bed in Kalbar, west of... |
 NY Post: NYPD Blotter NY Post: NYPD Blotter | 13h | |
|
|
|
 | Luke Combs, wife Nicole expecting second baby: 'Joining the 2 under 2 club' |
| Country singer Luke Combs has announced that he and his wife, Nicole Hocking, are expecting their second... |
 NY Post: NYPD Blotter NY Post: NYPD Blotter | 13h | |
|
|
|
| Police Cars Set on Fire in New York as City Awaits Trump Indictment - Newsweek |
| Police Cars Set on Fire in New York as City Awaits Trump Indictment Newsweek |
 "police" - Google News "police" - Google News | 14h | |
|
|
|
| CAUGHT ON CAMERA: Stolen Amazon truck chased by police - WWNY |
| CAUGHT ON CAMERA: Stolen Amazon truck chased by police WWNY |
 "police" - Google News "police" - Google News | 14h | |
|
|
|
| Seeing red? Va. state police to add red lights to vehicles - WTOP |
| Seeing red? Va. state police to add red lights to vehicles WTOP |
 "police" - Google News "police" - Google News | 14h | |
|
|
|
| Lavallette NJ sues to take back control of police force - Asbury Park Press |
| Lavallette NJ sues to take back control of police force Asbury Park Press |
 "police" - Google News "police" - Google News | 14h | |
|
|
|
| One killed, six injured in Kenya protests, police say - Reuters |
| One killed, six injured in Kenya protests, police say Reuters |
 "police" - Google News "police" - Google News | 14h | |
|
|
|
| Review says London police racist, misogynistic, homophobic - The Associated Press |
| Review says London police racist, misogynistic, homophobic The Associated Press |
 "police" - Google News "police" - Google News | 14h | |
|
|
|
| Police: 2 injured, 1 dead in Jeffersonville shooting - WHAS11.com |
| Police: 2 injured, 1 dead in Jeffersonville shooting WHAS11.com |
 "police" - Google News "police" - Google News | 14h | |
|
|
|
| FDNY vs. NYPD: Battle of the Badges boxing night to benefit 2 Staten Island-based... |
| FDNY vs. NYPD: Battle of the Badges boxing night to benefit 2 Staten Island-based charities SILive.com |
 "NYPD" - Google News "NYPD" - Google News | 14h | |
|
|
|
| NYPD, Secret Service preparing in case Trump in indicted - WCVB Boston |
| NYPD, Secret Service preparing in case Trump in indicted WCVB Boston |
 "NYPD" - Google News "NYPD" - Google News | 14h | |
|
|
|
| Police kill yet another unarmed Black man. Where's the body cam video? - USA TODAY |
| Police kill yet another unarmed Black man. Where's the body cam video? USA TODAY |
 "police" - Google News "police" - Google News | 14h | |
|
|
|
| Man Detained After Police Chase Ends With Crash in SW Miami-Dade - NBC 6 South Florida |
| Man Detained After Police Chase Ends With Crash in SW Miami-Dade NBC 6 South Florida |
 "police" - Google News "police" - Google News | 14h | |
|
|
|
| Fulton police lieutenant, wife charged with DWI on I-81 - syracuse.com |
| Fulton police lieutenant, wife charged with DWI on I-81 syracuse.com |
 "police" - Google News "police" - Google News | 14h | |
|
|
|
| Kissimmee police seek information on shooting that left 43-year-old ... - WKMG News... |
| Kissimmee police seek information on shooting that left 43-year-old ... WKMG News 6 & ClickOrlando |
 "police" - Google News "police" - Google News | 14h | |
|
|
|
| As New York Pays Out Millions In Police Misconduct Settlements ... - ProPublica |
| As New York Pays Out Millions In Police Misconduct Settlements ... ProPublica |
 "NYPD" - Google News "NYPD" - Google News | 14h | |
|
|
|
| Large police presence, coroner in Brookfield - WKBN.com |
| Large police presence, coroner in Brookfield WKBN.com |
 "police" - Google News "police" - Google News | 15h | |
|
|
|
| Police arrest man accused of stealing van, body from funeral home - Eyewitness News... |
| Police arrest man accused of stealing van, body from funeral home Eyewitness News 3 |
 "police" - Google News "police" - Google News | 15h | |
|
|
|
| State Police: 1 dead, 2 injured in 2 vehicle crash in Isle of Wight County - WAVY.com |
| State Police: 1 dead, 2 injured in 2 vehicle crash in Isle of Wight County WAVY.com |
 "police" - Google News "police" - Google News | 15h | |
|
|
|
| Man who threatened Bell Gardens High had guns, ammo ... - Los Angeles Times |
| Man who threatened Bell Gardens High had guns, ammo ... Los Angeles Times |
 "police" - Google News "police" - Google News | 15h | |
|
|
|
| Police investigating triple-shooting in South Los Angeles - CBS Los Angeles |
| Police investigating triple-shooting in South Los Angeles CBS Los Angeles |
 "police" - Google News "police" - Google News | 15h | |
|
|
|
| Fargo police chief slams city over lack of long-term treatment options - INFORUM |
| Fargo police chief slams city over lack of long-term treatment options INFORUM |
 "police" - Google News "police" - Google News | 15h | |
|
|
|
| Police: 1 man dead, female victim recovering after Meriden shooting - Eyewitness... |
| Police: 1 man dead, female victim recovering after Meriden shooting Eyewitness News 3 |
 "police" - Google News "police" - Google News | 15h | |
|
|
|
| Amazon Driver Delivers Package During Police Standoff - OutKick |
| Amazon Driver Delivers Package During Police Standoff OutKick |
 "police" - Google News "police" - Google News | 15h | |
|
|
|
 | Trump slams 'enemies,' Stormy Daniels' 'extortion plot' ahead of arrest: 'They are... |
| The ex-POTUS said he is being targeted by a series of "horrible radical left Democrat" investigations. |
 NY Post: NYPD Blotter NY Post: NYPD Blotter | 15h | |
|
|
|
 | Man rents space on Times Square billboard to propose to longtime girlfriend |
| In a sea of glimmering Broadway lights and advertisements in Times Square, one man had a special request for... |
 NY Post: NYPD Blotter NY Post: NYPD Blotter | 15h | |
|
|
|
| At Ukraine's front, police try to evacuate holdout families - WJXT News4JAX |
| At Ukraine's front, police try to evacuate holdout families WJXT News4JAX |
 "police" - Google News "police" - Google News | 15h | |
|
|
|
| Atlanta police lieutenant faces DUI charges, flees hospital after agreeing to a blood... |
| Atlanta police lieutenant faces DUI charges, flees hospital after agreeing to a blood test WSB Atlanta |
 "police" - Google News "police" - Google News | 15h | |
|
|
|
| Police prepare for response to possible arrest of former President Donald Trump -... |
| Police prepare for response to possible arrest of former President Donald Trump WMUR Manchester |
 "police" - Google News "police" - Google News | 15h | |
|
|
|
| 2 teens arrested after leading Beaumont Police on chase, crashing stolen vehicle... |
| 2 teens arrested after leading Beaumont Police on chase, crashing stolen vehicle 12newsnow.com KBMT-KJAC |
 "police" - Google News "police" - Google News | 15h | |
|
|
|
| NYPD identifies victim in broad daylight shooting in East Flatbush; 3 ... - News... |
| NYPD identifies victim in broad daylight shooting in East Flatbush; 3 ... News 12 Brooklyn |
 "NYPD" - Google News "NYPD" - Google News | 15h | |
|
|
|
| At Ukraine's front, police try to evacuate holdout families - The Associated Press |
| At Ukraine's front, police try to evacuate holdout families The Associated Press |
 "police" - Google News "police" - Google News | 16h | |
|
|
|
| At Ukraine's front, police try to evacuate holdout families - WPLG Local 10 |
| At Ukraine's front, police try to evacuate holdout families WPLG Local 10 |
 "police" - Google News "police" - Google News | 16h | |
|
|
|
| West Virginia State Police Superintendent Cahill resigns | News ... - Parkersburg... |
| West Virginia State Police Superintendent Cahill resigns | News ... Parkersburg News |
 "police" - Google News "police" - Google News | 16h | |
|
|
|
| New details emerge about police shooting in Park Ave neighborhood - News10NBC |
| New details emerge about police shooting in Park Ave neighborhood News10NBC |
 "police" - Google News "police" - Google News | 16h | |
|
|
|
| New video shows crash between Eagan Police Officer Kade Eggum and semi - CBS News |
| New video shows crash between Eagan Police Officer Kade Eggum and semi CBS News |
 "police" - Google News "police" - Google News | 16h | |
|
|
|
| Kent police investigating suspected hit-and-run after finding man in apartment driveway... |
| Kent police investigating suspected hit-and-run after finding man in apartment driveway KOMO News |
 "police" - Google News "police" - Google News | 16h | |
|
|
|
| Police seek occupants of car who shot at 2 vehicles in Davis County - KSL.com |
| Police seek occupants of car who shot at 2 vehicles in Davis County KSL.com |
 "police" - Google News "police" - Google News | 16h | |
|
|
|
| Police investigate death of woman in Cleveland's Slavic Village ... - cleveland.com |
| Police investigate death of woman in Cleveland's Slavic Village ... cleveland.com |
 "police" - Google News "police" - Google News | 16h | |
|
|
|
| At Ukraine's front, police try to evacuate holdout families - KSAT San Antonio |
| At Ukraine's front, police try to evacuate holdout families KSAT San Antonio |
 "police" - Google News "police" - Google News | 16h | |
|
|
|
| Police report, 3/21/23 - Statesboro Herald |
| Police report, 3/21/23 Statesboro Herald |
 "police" - Google News "police" - Google News | 16h | |
|
|
|
| Billings Police hold press conference after standoff on Birch Lane - KULR-TV |
| Billings Police hold press conference after standoff on Birch Lane KULR-TV |
 "police" - Google News "police" - Google News | 16h | |
|
|
|
| McAlester officer dies following crash during police funeral procession - KOKI FOX... |
| McAlester officer dies following crash during police funeral procession KOKI FOX 23 TULSA |
 "police" - Google News "police" - Google News | 16h | |
|
|
|
 | Maryland man arrested for attempting to kidnap middle schooler at bus stop |
| Jamaal Germany, 30, allegedly grabbed a Redland Middle School student on Towne Crest Drive near Washington... |
 NY Post: NYPD Blotter NY Post: NYPD Blotter | 16h | |
|
|
|
 | Dear Abby: My boyfriend's family and mine are going to meet — I'm scared |
| Dear Abby advises a woman who's nervous about her family meeting her boyfriend's family and a med student... |
 NY Post: NYPD Blotter NY Post: NYPD Blotter | 16h | |
|
|
|
 | Colorado dentist allegedly poisoned wife's protein shakes to start life with lover |
| The affidavit paints a picture of what led up to the alleged murder -- including a troubled marriage,... |
 NY Post: NYPD Blotter NY Post: NYPD Blotter | 16h | |
|
|
|
 | Dad takes on pack of aggressive monkeys as they lunge at his son in Thailand |
| Riley Whitelum and Elayna Carausu, who have amassed 1.8 million subscribers on YouTube with their travel... |
 NY Post: NYPD Blotter NY Post: NYPD Blotter | 16h | |
|
|
|
 | Japan's Kishida heading to Ukraine for talks with Zelensky |
| At the talks, Kishida will show his "absolute rejection to Russia's one-sided change to the status quo... |
 NY Post: NYPD Blotter NY Post: NYPD Blotter | 16h | |
|
|
|
| Tuesday briefing: Breaking down the damning new 300-page report into the Met Police's... |
| Tuesday briefing: Breaking down the damning new 300-page report into the Met Police's failures The Guardian |
 "police" - Google News "police" - Google News | 17h | |
|
|
|
| Casey report: Rape victim says no chance of reforming 'vile' Met Police - BBC |
| Casey report: Rape victim says no chance of reforming 'vile' Met Police BBC |
 "police" - Google News "police" - Google News | 17h | |
|
|
|
| Police news – March 21 | News, Sports, Jobs - The Express - Lock Haven Express |
| Police news – March 21 | News, Sports, Jobs - The Express Lock Haven Express |
 "police" - Google News "police" - Google News | 17h | |
|
|
|
| Columbia police officers will not face charges related to Jan. 11 fatal ... - KOMU... |
| Columbia police officers will not face charges related to Jan. 11 fatal ... KOMU 8 |
 "police" - Google News "police" - Google News | 17h | |
|
|
|
| Police didn't rush Uvalde gunman because they feared his AR-15, despite some of them... |
| Police didn't rush Uvalde gunman because they feared his AR-15, despite some of them carrying same weapon Washington... |
 "police" - Google News "police" - Google News | 17h | |
|
|
|
| Renton police ask for public's help after finding man shot in head - KOMO News |
| Renton police ask for public's help after finding man shot in head KOMO News |
 "police" - Google News "police" - Google News | 17h | |
|
|
|
| New Bedford police seize 2 guns, drugs from repeat offenders and ... - WLNE-TV (ABC6) |
| New Bedford police seize 2 guns, drugs from repeat offenders and ... WLNE-TV (ABC6) |
 "police" - Google News "police" - Google News | 17h | |
|
|
|
| Met Police: Casey review says predators allowed to thrive in force - BBC |
| Met Police: Casey review says predators allowed to thrive in force BBC |
 "police" - Google News "police" - Google News | 18h | |
|
|
|
| Hong Kong police put bailed pro-democracy leader Albert Ho back under arrest - The... |
| Hong Kong police put bailed pro-democracy leader Albert Ho back under arrest The Guardian |
 "police" - Google News "police" - Google News | 18h | |
|
|
|
| Probe Leads To Shakeup at West Virginia State Police - Wheeling Intelligencer |
| Probe Leads To Shakeup at West Virginia State Police Wheeling Intelligencer |
 "police" - Google News "police" - Google News | 18h | |
|
|
|
| Wheeling Police Officially Operating Out of New Headquarters - Wheeling Intelligencer |
| Wheeling Police Officially Operating Out of New Headquarters Wheeling Intelligencer |
 "police" - Google News "police" - Google News | 18h | |
|
|
|
| Fulton police lieutenant, wife charged with DWI on I-81 in Oswego County - syracuse.com |
| Fulton police lieutenant, wife charged with DWI on I-81 in Oswego County syracuse.com |
 "police" - Google News "police" - Google News | 18h | |
|
|
|
| Police: Man dead, woman injured after Meriden shooting - WTNH.com |
| Police: Man dead, woman injured after Meriden shooting WTNH.com |
 "police" - Google News "police" - Google News | 18h | |
|
|
|
| Hawai'i police renew request for 2 teen runaways : Big Island Now - Big Island Now |
| Hawai'i police renew request for 2 teen runaways : Big Island Now Big Island Now |
 "police" - Google News "police" - Google News | 18h | |
|
|
|
| Child dies after father removes her from daycare, attacks mother, leads police on... |
| Child dies after father removes her from daycare, attacks mother, leads police on chase, sheriff says KHOU.com |
 "police" - Google News "police" - Google News | 18h | |
|
|
|
 | Knicks' Tom Thibodeau thinks Rick Pitino will 'do a great job at St. John's' |
| Tom Thibodeau has known Rick Pitino for decades and endorses his blockbuster hiring as St. John's new... |
 NY Post: NYPD Blotter NY Post: NYPD Blotter | 18h | |
|
|
|
 | Julius Randle's magnificent Knicks night should have been much more |
| The pity is that this should've been one of the most memorable nights inside Madison Square Garden in... |
 NY Post: NYPD Blotter NY Post: NYPD Blotter | 18h | |
|
|
|
 | Justin Verlander admits he has 'some work to do' after rough Mets start |
| Verlander allowed two runs and two hits in his penultimate start of the Grapefruit League season. |
 NY Post: NYPD Blotter NY Post: NYPD Blotter | 18h | |
|
|
|
 | Francisco Lindor still bullish on Mets after Edwin Diaz injury: 'Broke my heart' |
| Francisco Lindor was celebrating perhaps the greatest victory of his career. |
 NY Post: NYPD Blotter NY Post: NYPD Blotter | 18h | |
|
|
|
 | North Koreans secretly resent Kim Jong Un's daughter's 'plump' cheeks: report |
| One resident in the Hermit Kingdom recently told Radio Free Asia's Korean Service people are noticing... |
 NY Post: NYPD Blotter NY Post: NYPD Blotter | 18h | |
|
|
|
 | The 'most important' thing Rick Pitino thinks needs fixing at St. John's |
| As Rick Pitino discussed with St. John's administrators how they could build a winner together, his priority... |
 NY Post: NYPD Blotter NY Post: NYPD Blotter | 18h | |
|
|
|
 | Los Angeles schools to close as district workers plan strike |
| Demonstrations are expected at schools across the city by members of Local 99 of the Service Employees... |
 NY Post: NYPD Blotter NY Post: NYPD Blotter | 18h | |
|
|
|
 | After foul ball nearly derailed career, Ian Hamilton eyes Yankees' pen |
| While Hamilton was in the Triple-A Charlotte dugout, a foul ball was blasted into his face and set off... |
 NY Post: NYPD Blotter NY Post: NYPD Blotter | 18h | |
|
|
|
 | Mets reliever Drew Smith extends strong spring by striking out side |
| Here are some scoops from the Mets' training day: Smoking Smith Drew Smith struck out the side in the... |
 NY Post: NYPD Blotter NY Post: NYPD Blotter | 18h | |
|
|
|
 | Cavaliers reportedly want to face Nets in the playoffs |
| This week will likely go a long way toward determining the Nets' playoff seed. |
 NY Post: NYPD Blotter NY Post: NYPD Blotter | 18h | |
|
|
|
 | Nets need to fix their rebounding woes to end losing streak |
| The word is out on the Nets. And the word is rebound. |
 NY Post: NYPD Blotter NY Post: NYPD Blotter | 18h | |
|
|
|
| Drug-resistant, potentially fatal fungus on the rise across US hospitals: CDC |
| Cases of Candida auris -- a fungus that can kill people with weakened immune systems -- have skyrocketed... |
 NY Post: NYPD Blotter NY Post: NYPD Blotter | 18h | |
|
|
|
| Hong Kong police detain key democrat on subversion charge - Reuters |
| Hong Kong police detain key democrat on subversion charge Reuters |
 "police" - Google News "police" - Google News | 18h | |
|
|
|
| 3 teenagers shot in West Philadelphia, police say - CBS Philly |
| 3 teenagers shot in West Philadelphia, police say CBS Philly |
 "police" - Google News "police" - Google News | 18h | |
|
|
|
| Roanoke Police Chief assumes new role as Assistant City Manager - WSLS 10 |
| Roanoke Police Chief assumes new role as Assistant City Manager WSLS 10 |
 "police" - Google News "police" - Google News | 18h | |
|
|
|
| Police: Ohio BCI investigating former Fremont officer over messages with minor -... |
| Police: Ohio BCI investigating former Fremont officer over messages with minor WTVG |
 "police" - Google News "police" - Google News | 18h | |
|
|
|
| Driver indicted for harassing Cleveland police, stalling emergency responses - WJW... |
| Driver indicted for harassing Cleveland police, stalling emergency responses WJW FOX 8 News Cleveland |
 "police" - Google News "police" - Google News | 18h | |
|
|
|
| Several officers injured, suspect arrested after RTC bus barricade in ... - KTNV... |
| Several officers injured, suspect arrested after RTC bus barricade in ... KTNV 13 Action News Las Vegas |
 "police" - Google News "police" - Google News | 19h | |
|
|
|
| Tucson police investigating shooting in Midtown - KOLD |
| Tucson police investigating shooting in Midtown KOLD |
 "police" - Google News "police" - Google News | 19h | |
|
|
|
| Sylvania Fire Department jokes with Toledo Police following fire - WTVG |
| Sylvania Fire Department jokes with Toledo Police following fire WTVG |
 "police" - Google News "police" - Google News | 19h | |
|
|
|
| Police identify man killed in Eunice shooting - KATC News |
| Police identify man killed in Eunice shooting KATC News |
 "police" - Google News "police" - Google News | 19h | |
|
|
|
| Police: Search for two males who fled shooting scene in Lompoc - KSBY News |
| Police: Search for two males who fled shooting scene in Lompoc KSBY News |
 "police" - Google News "police" - Google News | 19h | |
|
|
|
| Alabama freshman DB Tony Mitchell attempted to flee at 141 mph: police - New York... |
| Alabama freshman DB Tony Mitchell attempted to flee at 141 mph: police New York Post |
 "police" - Google News "police" - Google News | 19h | |
|
|
|
| Elgin officials break ground on new police station - KEYE TV CBS Austin |
| Elgin officials break ground on new police station KEYE TV CBS Austin |
 "police" - Google News "police" - Google News | 19h | |
|
|
|
| Macomb police chief to depart, interim police chief named - khqa.com |
| Macomb police chief to depart, interim police chief named khqa.com |
 "police" - Google News "police" - Google News | 19h | |
|
|
|
| Austin Police congratulate rabbi as new police chaplain - KXAN.com |
| Austin Police congratulate rabbi as new police chaplain KXAN.com |
 "police" - Google News "police" - Google News | 19h | |
|
|
|
| Crash through Philly police HQ highlighted facility's vulnerability - CBS Philly |
| Crash through Philly police HQ highlighted facility's vulnerability CBS Philly |
 "police" - Google News "police" - Google News | 19h | |
|
|
|
| Human remains fire pit NC | Cary neighbors and police in America's safest city 'disturbed'... |
| Human remains fire pit NC | Cary neighbors and police in America's safest city 'disturbed' after body... |
 "police" - Google News "police" - Google News | 19h | |
|
|
|
| Police: Man arrested in East Meadow with loaded gun was wanted ... - News 12 Long... |
| Police: Man arrested in East Meadow with loaded gun was wanted ... News 12 Long Island |
 "police" - Google News "police" - Google News | 19h | |
|
|
|
| Panama City Police Department arrests more than 60 people during Spring Break weekend... |
| Panama City Police Department arrests more than 60 people during Spring Break weekend WMBB - mypanhandle.com |
 "police" - Google News "police" - Google News | 19h | |
|
|
|
| Police: Man injured, woman in custody following shooting at ... - Channel3000.com... |
| Police: Man injured, woman in custody following shooting at ... Channel3000.com - WISC-TV3 |
 "police" - Google News "police" - Google News | 19h | |
|
|
|
| McAlester police officer dies after head-on collision - Mcalester News Capital |
| McAlester police officer dies after head-on collision Mcalester News Capital |
 "police" - Google News "police" - Google News | 19h | |
|
|
|
| Vallejo police shared data in violation of state law, watchdog alleges - The Vallejo... |
| Vallejo police shared data in violation of state law, watchdog alleges The Vallejo Sun |
 "police" - Google News "police" - Google News | 19h | |
|
|
|
 | Alabama freshman DB Tony Mitchell attempted to flee at 141 mph: police |
| Alabama freshman defensive back Tony Mitchell attempted to evade police by driving at 141 mph before... |
 NY Post: NYPD Blotter NY Post: NYPD Blotter | 19h | |
|
|
|
 | Experience ultimate luxury at this Punta Cana all-inclusive resort |
| Escape the cold and indulge your senses at Sanctuary Cap Cana, a Luxury Collection Adult All-Inclusive... |
 NY Post: NYPD Blotter NY Post: NYPD Blotter | 19h | |
|
|
|
 | Plan a dream vacation at these all-inclusive Caribbean resorts |
| Whether you're traveling with a significant other, a group of friends or your kids, it's always a good... |
 NY Post: NYPD Blotter NY Post: NYPD Blotter | 19h | |
|
|
|
 | Two empty NYPD cop cars set on fire in Flatiron District |
| An unidentified man approached parked police vehicles in the Flatiron District before setting them ablaze... |
 NY Post: NYPD Blotter NY Post: NYPD Blotter | 19h | |
|
|
|
 | Saudis release Saad Almadi — who was sentenced to 19 years for critical tweets |
| 72-year-old Saad Almadi still isn't allowed to return home to Florida due to a travel ban. |
 NY Post: NYPD Blotter NY Post: NYPD Blotter | 19h | |
|
|
|
 | Gerrit Cole isn't thinking about a potential Yankees opt-out |
| As one of the top pitchers in the game, Cole can impact an entire free-agent class, as he did before... |
 NY Post: NYPD Blotter NY Post: NYPD Blotter | 19h | |
|
|
|
 | Shohei Ohtani sparks epic Japan rally to beat Mexico, set up WBC final with US |
| Shohei Ohtani sparked a ninth-inning rally with a leadoff double, and Munetaka Murakami hit a walk-off,... |
 NY Post: NYPD Blotter NY Post: NYPD Blotter | 19h | |
|
|
|
 | PETA plans to install billboard to honor chickens killed in NYC truck fire |
| "Do they think a goose is going to fly by and think 'thank you, it means a lot?'" one Staten Island pol... |
 NY Post: NYPD Blotter NY Post: NYPD Blotter | 19h | |
|
|
|
 | Giancarlo Stanton flying under the radar in Aaron Judge's Yankees shadow |
| One of the biggest sluggers on the planet is able to escape at least some attention because another one... |
 NY Post: NYPD Blotter NY Post: NYPD Blotter | 19h | |
|
|
|
| Albuquerque police investigate southeast crash - KOAT New Mexico |
| Albuquerque police investigate southeast crash KOAT New Mexico |
 "police" - Google News "police" - Google News | 20h | |
|
|
|
| Police: 2 inmates taken into custody after escape from Newport News City Jail Annex... |
| Police: 2 inmates taken into custody after escape from Newport News City Jail Annex WAVY.com |
 "police" - Google News "police" - Google News | 20h | |
|
|
|
| Newborn abandoned at Springfield home: Police asking for help to locate mother -... |
| Newborn abandoned at Springfield home: Police asking for help to locate mother MassLive.com |
 "police" - Google News "police" - Google News | 20h | |
|
|
|
| Atlanta-based lawyer discusses lease agreement for proposed ... - WABE 90.1 FM |
| Atlanta-based lawyer discusses lease agreement for proposed ... WABE 90.1 FM |
 "police" - Google News "police" - Google News | 20h | |
|
|
|
| Missing Camden teen found safe, police say - WIS News 10 |
| Missing Camden teen found safe, police say WIS News 10 |
 "police" - Google News "police" - Google News | 20h | |
|
|
|
| Pasadena police investigating after body was found in east Harris ... - KTRK-TV |
| Pasadena police investigating after body was found in east Harris ... KTRK-TV |
 "police" - Google News "police" - Google News | 20h | |
|
|
|
| Riviera Beach Police mourn loss of veteran officer - WPEC |
| Riviera Beach Police mourn loss of veteran officer WPEC |
 "police" - Google News "police" - Google News | 20h | |
|
|
|
| NYPD's Judith Harrison blazes trail as commanding officer of counterterrorism division... |
| NYPD's Judith Harrison blazes trail as commanding officer of counterterrorism division WABC-TV |
 "NYPD" - Google News "NYPD" - Google News | 20h | |
|
|
|
| Brainerd names new police chief - Brainerd Dispatch |
| Brainerd names new police chief Brainerd Dispatch |
 "police" - Google News "police" - Google News | 20h | |
|
|
|
| Spokane police chief defends communications as activists call for him to resign -... |
| Spokane police chief defends communications as activists call for him to resign The Spokesman Review |
 "police" - Google News "police" - Google News | 20h | |
|
|
|
| Harrisburg police retire K-9 Zoe - WGAL Susquehanna Valley Pa. |
| Harrisburg police retire K-9 Zoe WGAL Susquehanna Valley Pa. |
 "police" - Google News "police" - Google News | 20h | |
|
|
|
| Kalamazoo police chase over stolen vehicle ends with rooftop arrest - MLive.com |
| Kalamazoo police chase over stolen vehicle ends with rooftop arrest MLive.com |
 "police" - Google News "police" - Google News | 20h | |
|
|
|
| Man dies in custody, suspected of swallowing illegal drugs, police say - WAVY.com |
| Man dies in custody, suspected of swallowing illegal drugs, police say WAVY.com |
 "police" - Google News "police" - Google News | 20h | |
|
|
|
| Police identify victim in north Austin homicide - KXAN.com |
| Police identify victim in north Austin homicide KXAN.com |
 "police" - Google News "police" - Google News | 20h | |
|
|
|
| Bridgewater Police Arrest and Charge Driver in Connection With Hit ... - Bridgewater,... |
| Bridgewater Police Arrest and Charge Driver in Connection With Hit ... Bridgewater, Massachusetts Police... |
 "police" - Google News "police" - Google News | 20h | |
|
|
|
| Hot Springs police investigate shooting in Laser-Trivista Right area - Hot Springs... |
| Hot Springs police investigate shooting in Laser-Trivista Right area Hot Springs Sentinel |
 "police" - Google News "police" - Google News | 20h | |
|
|
|
| Closing arguments heard in trial of retired Westfield police officer - Western Massachusetts... |
| Closing arguments heard in trial of retired Westfield police officer Western Massachusetts News |
 "police" - Google News "police" - Google News | 20h | |
|
|
|
| At least two NYPD vehicles, pile of trash set on fire in Manhattan - WABC-TV |
| At least two NYPD vehicles, pile of trash set on fire in Manhattan WABC-TV |
 "NYPD" - Google News "NYPD" - Google News | 20h | |
|
|
|
| Police: One dead following six-hour standoff in Evansville - Courier & Press |
| Police: One dead following six-hour standoff in Evansville Courier & Press |
 "police" - Google News "police" - Google News | 20h | |
|
|
|
| Las Vegas police send out evacuation order after old military explosive discovered... |
| Las Vegas police send out evacuation order after old military explosive discovered KLAS - 8 News Now |
 "police" - Google News "police" - Google News | 20h | |
|
|
|
| Police make arrest in Winfield beating death - The Times of Northwest Indiana |
| Police make arrest in Winfield beating death The Times of Northwest Indiana |
 "police" - Google News "police" - Google News | 20h | |
|
|
|
| Police: Search for two males who fled shooting scene in Lompoc - KSBY News |
| Police: Search for two males who fled shooting scene in Lompoc KSBY News |
 "police" - Google News "police" - Google News | 20h | |
|
|
|
| East Lyme police recover portion of cash stolen in scam - theday.com |
| East Lyme police recover portion of cash stolen in scam theday.com |
 "police" - Google News "police" - Google News | 20h | |
|
|
|
| Suspect escapes Chicago police custody, expert weighs in - CBS News |
| Suspect escapes Chicago police custody, expert weighs in CBS News |
 "police" - Google News "police" - Google News | 20h | |
|
|
|
 | Law enforcement not expecting possible Trump arraignment until next week: report |
| Former President Donald Trump is not expected to be arraigned until next week if he's indicted over an... |
 NY Post: NYPD Blotter NY Post: NYPD Blotter | 21h | |
|
|
|
 | Knicks squander Julius Randle's 57 points in streak-ending loss to Timberwolves |
| It didn't even matter in the end that Julius Randle absolutely could not be stopped. |
 NY Post: NYPD Blotter NY Post: NYPD Blotter | 21h | |
|
|
|
 | Bill Bradley impressed with Princeton's Sweet 16 run that brings back memories |
| The man Knicks fans remember fondly as Dollar Bill Bradley is asked: Do these Princeton Tigers remind... |
 NY Post: NYPD Blotter NY Post: NYPD Blotter | 21h | |
|
|
|
 | Alexander Skarsgård confirms birth of first child with girlfriend Tuva Novotny |
| The confirmation comes four months after the pair, who have kept most of their relationship private,... |
 NY Post: NYPD Blotter NY Post: NYPD Blotter | 21h | |
|
|
|
 | 'Wheel of Fortune' fans call 'BS,' claim 'unfair terminology' resulted in loss |
| Hell hath no fury like a "Wheel of Fortune" fan scorned. |
 NY Post: NYPD Blotter NY Post: NYPD Blotter | 21h | |
|
|
|
 | 'The Bachelor' Season 27, Episode 9 Recap: Who Does Zach Sleep With And Who Goes... |
| What in the world is this man doing? |
 NY Post: NYPD Blotter NY Post: NYPD Blotter | 21h | |
|
|
|
 | Firefighters battle massive blaze engulfing New Jersey church and school |
| Teams have been trying to put out the flames shooting out of the Fountain of Life Center in Burlington... |
 NY Post: NYPD Blotter NY Post: NYPD Blotter | 21h | |
|
|
|
 | Giants left looking for new starting center as Jon Feliciano bolts for 49ers |
| Jon Feliciano, who played in and started 15 games last season, agreed Monday to a one-year contract with... |
 NY Post: NYPD Blotter NY Post: NYPD Blotter | 21h | |
|
|
|
 | Darius Slayton brought back by unfinished Giants business: 'Be at the top' |
| Darius Slayton doesn't have a taste for the business side of the NFL after going through free agency... |
 NY Post: NYPD Blotter NY Post: NYPD Blotter | 21h | |
|
|
|
 | US says it's 'likely impossible' to eradicate invasive Burmese python population |
| The U.S. Geological Survey (USGS) said Burmese pythons in southern Florida represent "one of the most... |
 NY Post: NYPD Blotter NY Post: NYPD Blotter | 21h | |
|
|
|
 | Eduardo Escobar's Mets return comes with Brett Baty competition at third |
| Eduardo Escobar enjoyed the "unbelievable" energy that came with playing in the World Baseball Classic... |
 NY Post: NYPD Blotter NY Post: NYPD Blotter | 21h | |
|
|
|
 | Andy Cohen reveals why he yelled at 'a–hole' Larsa Pippen at 'RHOM' reunion |
| The Bravo honcho explained that Pippen made a comment that felt personal to him, saying he "got super... |
 NY Post: NYPD Blotter NY Post: NYPD Blotter | 21h | |
|
|
|
 | Rick Pitino and St. John's can save one another |
| It is a marriage and a merger of mutual salvation. |
 NY Post: NYPD Blotter NY Post: NYPD Blotter | 21h | |
|
|
|
 | Republicans celebrate as Biden signs resolution to reverse DC crime bill |
| President Biden on Monday signed a Republican-sponsored bill to block a controversial update to Washington,... |
 NY Post: NYPD Blotter NY Post: NYPD Blotter | 21h | |
|
|
|
| London's Metropolitan Police lets predators flourish, review concludes - CNN |
| London's Metropolitan Police lets predators flourish, review concludes CNNLondon's Met Police found... |
 "police" - Google News "police" - Google News | 21h | |
|
|
|
| Upstate police department announces death of K-9 - WYFF4 Greenville |
| Upstate police department announces death of K-9 WYFF4 Greenville |
 "police" - Google News "police" - Google News | 21h | |
|
|
|
| Sylvania Fire Department jokes with Toledo Police following fire - WTVG |
| Sylvania Fire Department jokes with Toledo Police following fire WTVG |
 "police" - Google News "police" - Google News | 21h | |
|
|
|
| Sebewaing mourns the loss of beloved police officer and public ... - WJRT |
| Sebewaing mourns the loss of beloved police officer and public ... WJRT |
 "police" - Google News "police" - Google News | 21h | |
|
|
|
| Police: Man arrested in East Meadow with loaded gun was wanted ... - News 12 Long... |
| Police: Man arrested in East Meadow with loaded gun was wanted ... News 12 Long Island |
 "police" - Google News "police" - Google News | 21h | |
|
|
|
| Fremont police officer resigns, was being investigated for allegedly ... - The News-Messenger |
| Fremont police officer resigns, was being investigated for allegedly ... The News-Messenger |
 "police" - Google News "police" - Google News | 21h | |
|
|
|
| Arlington Police Provide Update on March 20, 2023, Shooting at ... - City of Arlington |
| Arlington Police Provide Update on March 20, 2023, Shooting at ... City of Arlington |
 "police" - Google News "police" - Google News | 21h | |
|
|
|
| Bobcat Driver Leads Brookline Officers on ‘Extremely Slow' Police Pursuit -... |
| Bobcat Driver Leads Brookline Officers on 'Extremely Slow' Police Pursuit NBC10 Boston |
 "police" - Google News "police" - Google News | 21h | |
|
|
|
| Police respond to crash in southeast Fort Wayne - WANE |
| Police respond to crash in southeast Fort Wayne WANE |
 "police" - Google News "police" - Google News | 21h | |
|
|
|
| Disney+ Adds Buddy Cop Series 'Han River Police' to K-Drama Slate - Hollywood Reporter |
| Disney+ Adds Buddy Cop Series 'Han River Police' to K-Drama Slate Hollywood Reporter |
 "police" - Google News "police" - Google News | 21h | |
|
|
|
| Violent youth fights at popular SF mall prompt police presence - SFGATE |
| Violent youth fights at popular SF mall prompt police presence SFGATE |
 "police" - Google News "police" - Google News | 21h | |
|
|
|
| Baltimore police announce arrest in killing of Patterson High School student - WBAL... |
| Baltimore police announce arrest in killing of Patterson High School student WBAL TV Baltimore |
 "police" - Google News "police" - Google News | 21h | |
|
|
|
| SLO police: Roughly 4000 people gathered for St. Patrick's Day celebrations - KSBY... |
| SLO police: Roughly 4000 people gathered for St. Patrick's Day celebrations KSBY News |
 "police" - Google News "police" - Google News | 21h | |
|
|
|
| 'Please use extra caution:' Police in South Boston remind the public on school bus... |
| 'Please use extra caution:' Police in South Boston remind the public on school bus safety WSET |
 "police" - Google News "police" - Google News | 21h | |
|
|
|
| Police reports show not everyone behaved during St. Patrick's Day ... - The Montana... |
| Police reports show not everyone behaved during St. Patrick's Day ... The Montana Standard |
 "police" - Google News "police" - Google News | 21h | |
|
|
|
| West Virginia state police superintendent resigns amid probe - ABC News |
| West Virginia state police superintendent resigns amid probe ABC News |
 "police" - Google News "police" - Google News | 21h | |
|
|
|
| Police suspect recent Portland burglaries linked to similar cases ... - Press Herald |
| Police suspect recent Portland burglaries linked to similar cases ... Press Herald |
 "police" - Google News "police" - Google News | 21h | |
|
|
|
| Police seek video of early-Saturday shooting death of Beaumont man as investigation... |
| Police seek video of early-Saturday shooting death of Beaumont man as investigation continues 12newsnow.com... |
 "police" - Google News "police" - Google News | 21h | |
|
|
|
| Police investigating suspicious death in Northern New York - WCAX |
| Police investigating suspicious death in Northern New York WCAX |
 "police" - Google News "police" - Google News | 21h | |
|
|
|
| Man shot by Taylorsville police placed under arrest - KSL.com |
| Man shot by Taylorsville police placed under arrest KSL.com |
 "police" - Google News "police" - Google News | 22h | |
|
|
|
| Carjacker Leaves Trail of Destruction, Injury in Northern Virginia: Police - NBC4... |
| Carjacker Leaves Trail of Destruction, Injury in Northern Virginia: Police NBC4 Washington |
 "police" - Google News "police" - Google News | 22h | |
|
|
|
| Police searching for missing NKY teen last seen on St. Patrick's Day - FOX19 |
| Police searching for missing NKY teen last seen on St. Patrick's Day FOX19 |
 "police" - Google News "police" - Google News | 22h | |
|
|
|
| Teen shot woman who caught him breaking into vehicle, Omaha Police say - KLKN |
| Teen shot woman who caught him breaking into vehicle, Omaha Police say KLKN |
 "police" - Google News "police" - Google News | 22h | |
|
|
|
| Police Look for Thieves After Car Stolen From Avon Home in Broad Daylight - NBC Connecticut |
| Police Look for Thieves After Car Stolen From Avon Home in Broad Daylight NBC Connecticut |
 "police" - Google News "police" - Google News | 22h | |
|
|
|
| Kalamazoo police chase over stolen vehicle ends with rooftop arrest - MLive.com |
| Kalamazoo police chase over stolen vehicle ends with rooftop arrest MLive.com |
 "police" - Google News "police" - Google News | 22h | |
|
|
|
| Virginia State Police cars feature new red lights following VTTI safety ... - WSLS... |
| Virginia State Police cars feature new red lights following VTTI safety ... WSLS 10 |
 "police" - Google News "police" - Google News | 22h | |
|
|
|
| Jeffersonville police investigate triple shooting that killed 1, injured 2 - WAVE... |
| Jeffersonville police investigate triple shooting that killed 1, injured 2 WAVE 3 |
 "police" - Google News "police" - Google News | 22h | |
|
|
|
| Video shows Oxnard police shoot, kill man who charged while ... - Los Angeles Times |
| Video shows Oxnard police shoot, kill man who charged while ... Los Angeles Times |
 "police" - Google News "police" - Google News | 22h | |
|
|
|
| Kissimmee police searching for person who shot, killed man Saturday afternoon - WFTV... |
| Kissimmee police searching for person who shot, killed man Saturday afternoon WFTV Orlando |
 "police" - Google News "police" - Google News | 22h | |
|
|
|
| Man who stole police vehicle sentenced to prison - WWNY |
| Man who stole police vehicle sentenced to prison WWNY |
 "police" - Google News "police" - Google News | 22h | |
|
|
|
| Hebron woman located at Mohegan Sun parking garage after police ... - theday.com |
| Hebron woman located at Mohegan Sun parking garage after police ... theday.com |
 "police" - Google News "police" - Google News | 22h | |
|
|
|
| Roanoke man backs into police vehicle before arrest for June 2022 ... - WSLS 10 |
| Roanoke man backs into police vehicle before arrest for June 2022 ... WSLS 10 |
 "police" - Google News "police" - Google News | 22h | |
|
|
|
| Police say they shot and killed a man in the Park Avenue ... - WXXI News |
| Police say they shot and killed a man in the Park Avenue ... WXXI News |
 "police" - Google News "police" - Google News | 22h | |
|
|
|
| Child dies after father removes her from daycare, attacks mother, leads police on... |
| Child dies after father removes her from daycare, attacks mother, leads police on chase, sheriff says KHOU.com |
 "police" - Google News "police" - Google News | 22h | |
|
|
|
| Longtime Vermont State Police trooper facing 16 criminal charges - Brattleboro Reformer |
| Longtime Vermont State Police trooper facing 16 criminal charges Brattleboro Reformer |
 "police" - Google News "police" - Google News | 22h | |
|
|
|
| Denver is paying out $110000 for two liability claims involving police - Denverite |
| Denver is paying out $110000 for two liability claims involving police Denverite |
 "police" - Google News "police" - Google News | 22h | |
|
|
|
| Texas lawmakers consider school safety bills as deadly shooting occurs at an Arlington... |
| Texas lawmakers consider school safety bills as deadly shooting occurs at an Arlington high school CBS... |
 "Robb Elementary Uvalde" - Google News "Robb Elementary Uvalde" - Google News | 22h | |
|
|
|
 | Virginia teacher shot by young student speaks out, describes how some days she 'can't... |
| "For going through what I've gone through I try to stay positive, have a positive outlook on what happened... |
 NY Post: NYPD Blotter NY Post: NYPD Blotter | 22h | |
|
|
|
 | Sarah Snook is pregnant, debuts baby bump at 'Succession' premiere |
| Snook, 35, debuted her baby bump at the Season 4 premiere of "Succession" on Monday. The actress married... |
 NY Post: NYPD Blotter NY Post: NYPD Blotter | 22h | |
|
|
|
 | Mets should look to Alexis Diaz to fill older brother's closer void |
| The Mets' answer to their sudden closing issue is as easy as checking out the Diaz family tree. |
 NY Post: NYPD Blotter NY Post: NYPD Blotter | 22h | |
|
|
|
 | Rick Pitino plans to quickly make St. John's a 'special ticket again' |
| After over decades of disappointment, mediocre results and bottom-half Big East finishes, there is legitimate... |
 NY Post: NYPD Blotter NY Post: NYPD Blotter | 22h | |
|
|
|
 | 29-year-old woman who posed as teen student wanted to relive HS experience: lawyer |
| The 29-year-old woman who enrolled herself in a New Jersey high school posing as a teenage student was... |
 NY Post: NYPD Blotter NY Post: NYPD Blotter | 22h | |
|
|
|
 | Grizzlies 'hopeful' Ja Morant returns Wednesday after NBA suspension |
| Ja Morant's return to the Grizzlies after an NBA suspension for a series of off-court missteps, including... |
 NY Post: NYPD Blotter NY Post: NYPD Blotter | 22h | |
|
|
|
 | 90-year-old tortoise Mr. Pickles welcomes three newborns at Houston Zoo |
| The 90-year-old endangered tortoise Mr. Pickles, The Houston Zoo's oldest animal, has welcomed three... |
 NY Post: NYPD Blotter NY Post: NYPD Blotter | 22h | |
|
|
|
 | ESPN star Michael Wilbon opens up about working through challenges of recent surgery |
| Michael Wilbon, one of the biggest stars at ESPN, remains in positive spirits after facing some recent... |
 NY Post: NYPD Blotter NY Post: NYPD Blotter | 22h | |
|
|
|
 | Earth 'nearing point of no return,' greenhouse gas emissions must be cut: report |
| The UN has warned that global greenhouse gas emissions must be slashed quickly and drastically to avoid... |
 NY Post: NYPD Blotter NY Post: NYPD Blotter | 22h | |
|
|
|
 | Missing Americans' moms make desperate plea — help find our kidnapped sons in Mexico |
| Over 500 Americans are feared missing in Mexico. Ernesto Garnica and Robert Torres' mothers tell the... |
 NY Post: NYPD Blotter NY Post: NYPD Blotter | 22h | |
|
|
|
 | Trump's potential arrest distracts from legislative priorities at House GOP retreat |
| Former President Donald Trump's looming indictment stole focus during press conferences at the House... |
 NY Post: NYPD Blotter NY Post: NYPD Blotter | 22h | |
|
|
|
 | Biden signs bill to declassify info on COVID-19 origins |
| President Biden on Monday signed a bill unanimously passed by Congress that requires the declassification... |
 NY Post: NYPD Blotter NY Post: NYPD Blotter | 22h | |
|
|
|
 | The '80s NYC nightlife wasn't shootings and lootings, it was party time |
| Still guided by the Voice When skirts were long and subways safe Michael Musto was a musto. Everyone... |
 NY Post: NYPD Blotter NY Post: NYPD Blotter | 22h | |
|
|
|
| Chicopee Police to offer women's self-defense classes in April - Western Massachusetts... |
| Chicopee Police to offer women's self-defense classes in April Western Massachusetts News |
 "police" - Google News "police" - Google News | 22h | |
|
|
|
| Review says London police racist, misogynistic, homophobic - ABC News |
| Review says London police racist, misogynistic, homophobic ABC News |
 "police" - Google News "police" - Google News | 22h | |
|
|
|
| Met Police: Women and children failed by 'boys' club', review finds. - BBC |
| Met Police: Women and children failed by 'boys' club', review finds. BBC |
 "police" - Google News "police" - Google News | 22h | |
|
|
|
| Police investigating shooting in Scranton's west side - WNEP Scranton/Wilkes-Barre |
| Police investigating shooting in Scranton's west side WNEP Scranton/Wilkes-Barre |
 "police" - Google News "police" - Google News | 22h | |
|
|
|
| Mobile Police searching for 'armed, dangerous' man wanted for attempted murder -... |
| Mobile Police searching for 'armed, dangerous' man wanted for attempted murder WKRG News 5 |
 "police" - Google News "police" - Google News | 22h | |
|
|
|
| West Virginia state police superintendent resigns amid probe - ABC News |
| West Virginia state police superintendent resigns amid probe ABC News |
 "police" - Google News "police" - Google News | 22h | |
|
|
|
| Macomb police chief announces departure, interim police chief appointed - WGEM |
| Macomb police chief announces departure, interim police chief appointed WGEM |
 "police" - Google News "police" - Google News | 22h | |
|
|
|
| Springfield Police arrest suspect in Cooley Street bank robbery - Western Massachusetts... |
| Springfield Police arrest suspect in Cooley Street bank robbery Western Massachusetts News |
 "police" - Google News "police" - Google News | 22h | |
|
|
|
| Missing: Asheville police ask for help locating woman last seen over a month ago... |
| Missing: Asheville police ask for help locating woman last seen over a month ago WLOS |
 "police" - Google News "police" - Google News | 22h | |
|
|
|
| Harrisburg Police K-9 retires after cancer diagnosis - ABC27 |
| Harrisburg Police K-9 retires after cancer diagnosis ABC27 |
 "police" - Google News "police" - Google News | 22h | |
|
|
|
 | Saved Web Pages - Daily Report at 9 p.m. - Is Donald Trump being arrested? Here are... |
| ... |
 The News And Times The News And Times | 22h | |
|
|
|
| Police want to install 500 cameras on city streets and San Diegans ... - KPBS |
| Police want to install 500 cameras on city streets and San Diegans ... KPBS |
 "police" - Google News "police" - Google News | 23h | |
|
|
|
| Met police found to be institutionally racist, misogynistic and homophobic - The... |
| Met police found to be institutionally racist, misogynistic and homophobic The GuardianLondon's Met... |
 "police" - Google News "police" - Google News | 23h | |
|
|
|
| Philadelphia reaches $9.25m settlement over 2020 police response | Police News -... |
| Philadelphia reaches $9.25m settlement over 2020 police response | Police News Al Jazeera English |
 "police" - Google News "police" - Google News | 23h | |
|
|
|
| No perp walk for Trump expected in NYC, police sources say - New York Daily News |
| No perp walk for Trump expected in NYC, police sources say New York Daily News |
 "police" - Google News "police" - Google News | 23h | |
|
|
|
| Police identify woman who died following Mendon fire - WCAX |
| Police identify woman who died following Mendon fire WCAX |
 "police" - Google News "police" - Google News | 23h | |
|
|
|
| Police: Dentist killed wife by lacing shakes with poison - ABC News |
| Police: Dentist killed wife by lacing shakes with poison ABC News |
 "police" - Google News "police" - Google News | 23h | |
|
|
|
| Man injured in Middleton shooting Monday, police say; woman in ... - Channel3000.com... |
| Man injured in Middleton shooting Monday, police say; woman in ... Channel3000.com - WISC-TV3 |
 "police" - Google News "police" - Google News | 23h | |
|
|
|
| Ocala teacher accused of soliciting child porn from girl's mother ... - WKMG News... |
| Ocala teacher accused of soliciting child porn from girl's mother ... WKMG News 6 & ClickOrlando |
 "police" - Google News "police" - Google News | 23h | |
|
|
|
| Man with knife killed by police in Fresno identified. Three officers fired their... |
| Man with knife killed by police in Fresno identified. Three officers fired their weapons Fresno Bee |
 "police" - Google News "police" - Google News | 23h | |
|
|
|
| Copley police search for more suspects in 3 Summit County killings; potential 4th... |
| Copley police search for more suspects in 3 Summit County killings; potential 4th victim 'played dead'... |
 "police" - Google News "police" - Google News | 23h | |
|
|
|
| Indiana police continue dayslong search for missing 14-year-old believed to be in... |
| Indiana police continue dayslong search for missing 14-year-old believed to be in 'extreme danger' Fox... |
 "police" - Google News "police" - Google News | 23h | |
|
|
|
| Extra Time: NYPD prepares ahead of potential Trump indictment - WABC-TV |
| Extra Time: NYPD prepares ahead of potential Trump indictment WABC-TV |
 "NYPD" - Google News "NYPD" - Google News | 23h | |
|
|
|
| NYPD: Girl, 17, arrested after stealing car from Staten Island home Monday morning... |
| NYPD: Girl, 17, arrested after stealing car from Staten Island home Monday morning SILive.com |
 "NYPD" - Google News "NYPD" - Google News | 23h | |
|
|
|
| 'So much blood:' Medics tell what they saw and did after Uvalde massacre - CNN |
| 'So much blood:' Medics tell what they saw and did after Uvalde massacre CNN |
 "Robb Elementary Uvalde" - Google News "Robb Elementary Uvalde" - Google News | 23h | |
|
|
|
| Philadelphia reaches $9.25m settlement over 2020 police response - Al Jazeera English |
| Philadelphia reaches $9.25m settlement over 2020 police response Al Jazeera English |
 "police" - Google News "police" - Google News | 23h | |
|
|
|
| Man shot by Taylorsville police arrested, moved to jail - KSL.com |
| Man shot by Taylorsville police arrested, moved to jail KSL.com |
 "police" - Google News "police" - Google News | 23h | |
|
|
|
| Police respond to crash in downtown Lincoln - KOLN |
| Police respond to crash in downtown Lincoln KOLN |
 "police" - Google News "police" - Google News | 23h | |
|
|
|
| Dallas police officer fired after bodycam shows him use 'excessive force' on chase... |
| Dallas police officer fired after bodycam shows him use 'excessive force' on chase suspect WFAA.com |
 "police" - Google News "police" - Google News | 23h | |
|
|
|
| Former Utah tech exec was killed in an 'ambush.' Police have ... - KSL.com |
| Former Utah tech exec was killed in an 'ambush.' Police have ... KSL.com |
 "police" - Google News "police" - Google News | 23h | |
|
|
|
| Police: Car stolen at gunpoint outside Bridgeport shopping center - CTPost |
| Police: Car stolen at gunpoint outside Bridgeport shopping center CTPost |
 "police" - Google News "police" - Google News | 23h | |
|
|
|
| Hartford Police Investigating After Window of Police Vehicle Was Smashed - NBC Connecticut |
| Hartford Police Investigating After Window of Police Vehicle Was Smashed NBC Connecticut |
 "police" - Google News "police" - Google News | 23h | |
|
|
|
| Body found in Fredericktown, Mo. park; police investigating - KFVS |
| Body found in Fredericktown, Mo. park; police investigating KFVS |
 "police" - Google News "police" - Google News | 23h | |
|
|
|
| Green Bay Police Department is enhancing wellness inside the ... - Green Bay Press... |
| Green Bay Police Department is enhancing wellness inside the ... Green Bay Press Gazette |
 "police" - Google News "police" - Google News | 23h | |
|
|
|
| Police: Lafayette teen wounded by self-inflicted gunshot - Journal & Courier |
| Police: Lafayette teen wounded by self-inflicted gunshot Journal & Courier |
 "police" - Google News "police" - Google News | 23h | |
|
|
|
| Kenya opposition leader calls for weekly protests after being tear ... - CNN |
| Kenya opposition leader calls for weekly protests after being tear ... CNN |
 "police" - Google News "police" - Google News | 23h | |
|
|
|
| Police supervisor in Tyre Nichols' death retired with benefits before ... - WPVI-TV |
| Police supervisor in Tyre Nichols' death retired with benefits before ... WPVI-TV |
 "police" - Google News "police" - Google News | 23h | |
|
|
|
 | Michelin-starred chef offers NYC restaurant workers massive 70% discount on menu... |
| "I just started to think about the service industry, which became the most underserved community, Fraser... |
 NY Post: NYPD Blotter NY Post: NYPD Blotter | 1d | |
|
|
|
 | Martina Navratilova: 'Complicated' adoption likely won't happen after cancer battle |
| "That's definitely put on hold, and I don't think it's going to happen," said the tennis legend, who... |
 NY Post: NYPD Blotter NY Post: NYPD Blotter | 1d | |
|
|
|
 | DA Bragg to cross the Rubicon and divide the nation by indicting Trump |
| All signs point to Alvin Bragg, Manhattan's progressive prosecutor, indicting Donald Trump for his 2016... |
 NY Post: NYPD Blotter NY Post: NYPD Blotter | 1d | |
|
|
|
 | Cat survives 6 days trapped in gas explosion rubble: 'He was a little cross' |
| The fortuitous feline, a ragdoll moggy breed, was presumed dead from the March 13 blast, which killed... |
 NY Post: NYPD Blotter NY Post: NYPD Blotter | 1d | |
|
|
|
 | Washington ignores Putin's designs on Moldova at its peril |
| One of Europe's most modest countries is becoming a major center of conflict. |
 NY Post: NYPD Blotter NY Post: NYPD Blotter | 1d | |
|
|
|
 | Rangers' Ryan Lindgren on precipice of injury return |
| The Rangers' defense corps may finally be at full strength. |
 NY Post: NYPD Blotter NY Post: NYPD Blotter | 1d | |
|
|
|
 | Fan poops in aisle near Hillary and Chelsea Clinton at Broadway show |
| An insider added, "The house crew dealt with it very appropriately and quickly, and Hillary and Chelsea... |
 NY Post: NYPD Blotter NY Post: NYPD Blotter | 1d | |
|
|
|
 | MMA fighter Iuri Lapicus dead at 27 after motorcycle crash in Italy |
| Iuri Lapicus, a professional MMA fighter, has died at the age of 27 after getting into a motorcycle accident... |
 NY Post: NYPD Blotter NY Post: NYPD Blotter | 1d | |
|
|
|
 | Stream It Or Skip It: Prime Video's 'Class of '07,' A Comedy Where A Group Of Old... |
| What happens when the only survivors of the apocalypse are the people who showed up to your high school... |
 NY Post: NYPD Blotter NY Post: NYPD Blotter | 1d | |
|
|
|
 | Gabby Prescod reacts to Ciara Miller, Mya Allen calling her 'surface-level' |
| "Summer House" newcomer Gabby Prescod addressed how she felt to hear her co-stars Mya Allen and Ciara... |
 NY Post: NYPD Blotter NY Post: NYPD Blotter | 1d | |
|
|
|
 | Police overtime set to soar to record $740M as NYPD faces staffing crunch |
| The news of the blown police budget comes as Adams faces a costly migrant crisis and a city budget deficit... |
 NY Post: NYPD Blotter NY Post: NYPD Blotter | 1d | |
|
|
|
 | Whoopi Goldberg shocks with new look on 'The View' — here's why |
| Something was noticeably different about her appearance during Monday's episode. |
 NY Post: NYPD Blotter NY Post: NYPD Blotter | 1d | |
|
|
|
 | Good government groups plead with New York Democrats to end 'love affair' with wasteful... |
| A $455 million loan to Belmont Park is on track to get approved alongside $480 million in expanded tax... |
 NY Post: NYPD Blotter NY Post: NYPD Blotter | 1d | |
|
|
|
 | Rangers have late season test against Metro-best Hurricanes |
| The next two games will be a measuring stick for the playoffs. |
 NY Post: NYPD Blotter NY Post: NYPD Blotter | 1d | |
|
|
|
 | Mercyhurst's Carson Briere charged for pushing wheelchair down bar stairs |
| Mercyhurst hockey player Carson Briere is facing three misdemeanor charges for pushing an unoccupied... |
 NY Post: NYPD Blotter NY Post: NYPD Blotter | 1d | |
|
|
|
 | Ex-Vermont state trooper accused of stealing $14K Rolex, ADHD meds |
| The Rolex was recovered at the home of a relative of DiGenova in Massachusetts, but the other items are... |
 NY Post: NYPD Blotter NY Post: NYPD Blotter | 1d | |
|
|
|
 | NYC loft where Heath Ledger died of drug overdose sells for $14.25M |
| In 2008, at the age of 28, the Aussie actor died of an accidental drug overdose in this 419-421 Broome... |
 NY Post: NYPD Blotter NY Post: NYPD Blotter | 1d | |
|
|
|
 | We love NYC — so let's take it back from the brink |
| Leaders from business, labor and communities across the city joined Gov. Kathy Hochul and Mayor Eric... |
 NY Post: NYPD Blotter NY Post: NYPD Blotter | 1d | |
|
|
|
 | 'Hellish' solar tornado erupts 74K miles high: 'Never seen anything like it' |
| The spiraling solar flare, comprised of unfathomably hot plasma caught in a frenzy of competing magnetic... |
 NY Post: NYPD Blotter NY Post: NYPD Blotter | 1d | |
|
|
|
 | Joe Manchin blasts Biden's 'absolutely infuriating' ESG veto |
| Accusing him of putting "radical policy" ahead of the country's "economic, energy and national security... |
 NY Post: NYPD Blotter NY Post: NYPD Blotter | 1d | |
Comments
Post a Comment